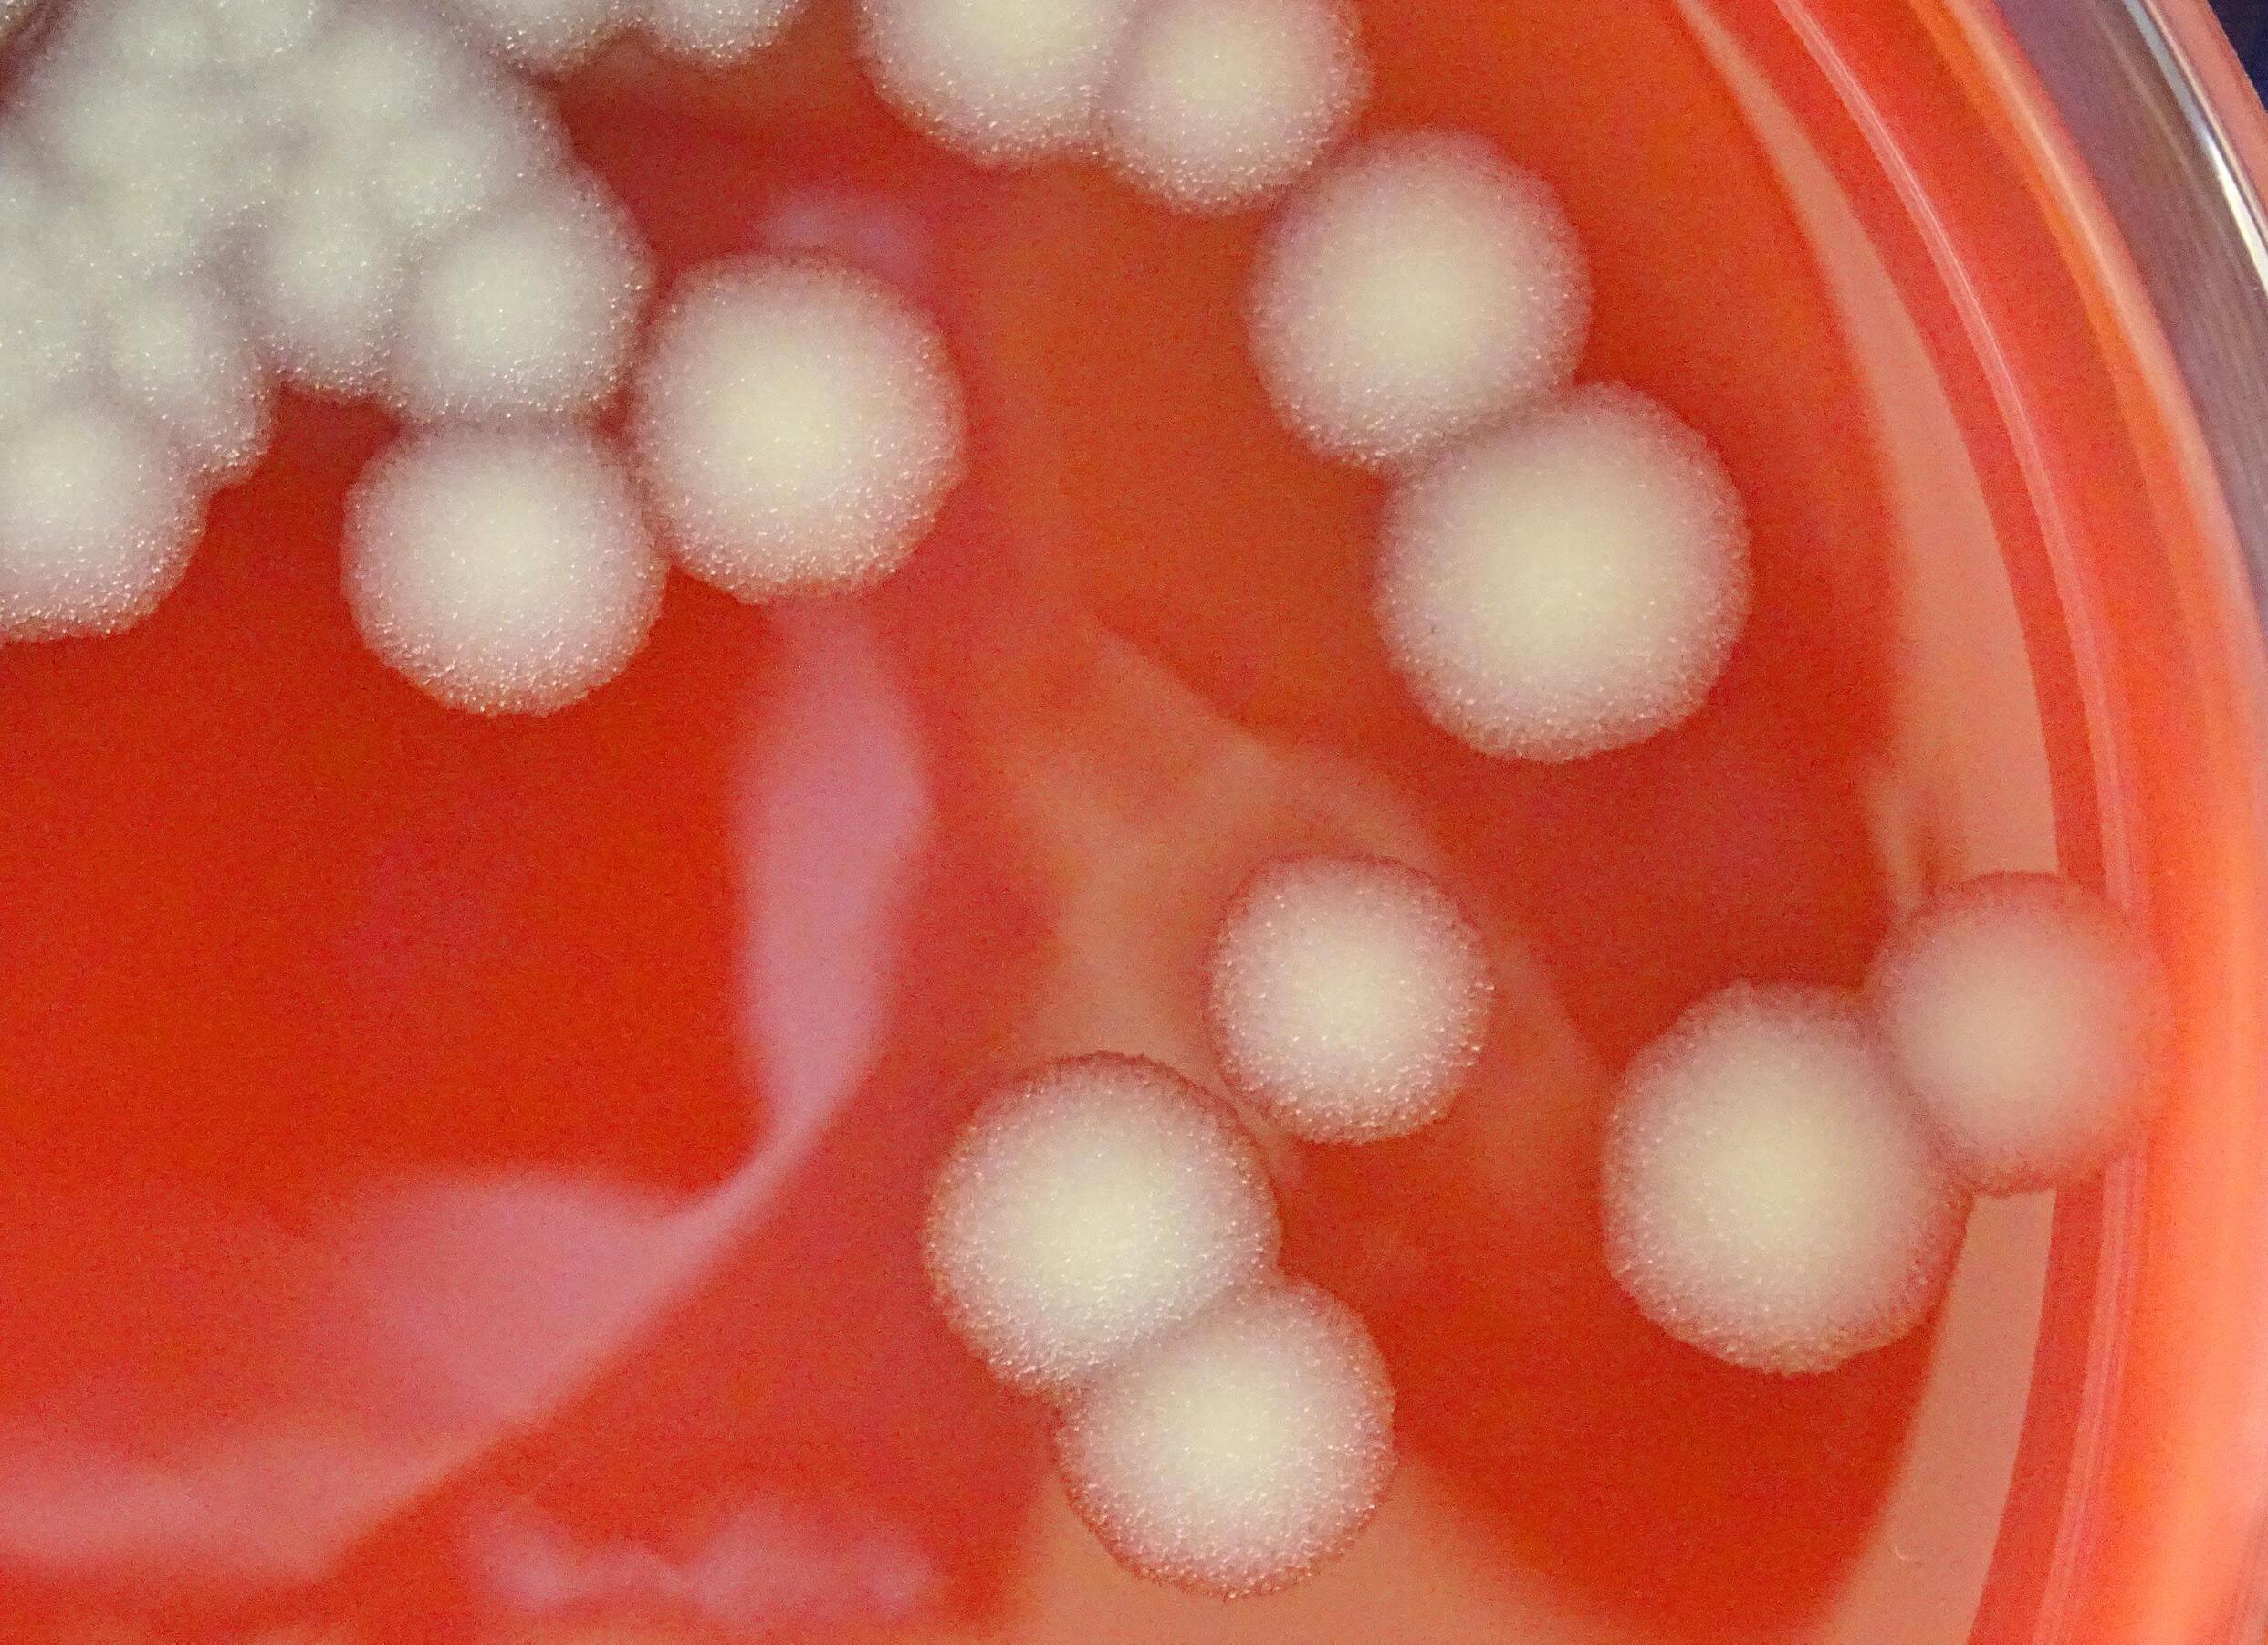

Fitness-Check beim Zwischenstopp Parasitenbelastung bei Zugvögeln


Fitness-Check beim Zwischenstopp Parasitenbelastung bei Zugvögeln

Aktuelle Forschung zu den Nachhaltigkeitszielen der UNO
ab Seite 10
Tipps fürs Tier Wie werden Antibiogramme erstellt? Seite 30
eHealth: Das Projekt HOLSTEIN verbessert die Tiergesundheit mittels Technologie Seite 14
Tierschutzwissenschaften bei Nutztieren: Good Vibes im Stall Seite 22
Bestandsbetreuung bei Wiederkäuern: Zwischen Stall und Petrischale
Seite 32
Analytische Chemie: Toxinen auf der Spur Seite 40
Jürgen Rehage
Vizerektor für Lehre und klinische Veterinärmedizin
Die Weltgesundheitsorganisation hat 17 Entwicklungsziele festgelegt, um eine nachhaltige Zukunft für unseren Planeten zu erreichen. Eines davon ist das Sustainable Development Goal/SDG 3: „Gesundheit und Wohlergehen“. Dieses Ziel ist von entscheidender Bedeutung, da es darauf abzielt, das Wohlergehen und eine Gesundheitsversorgung für alle Menschen zu gewährleisten.
Die Tiermedizin spielt dabei eine entscheidende Rolle, insbesondere in Bezug auf Infektionskrankheiten. Viele virale, bakterielle oder parasitäre Krankheiten können als Zoonosen von Tieren auf Menschen und umgekehrt übertragen werden. Indem wir die Gesundheit von Nutz-, Haus- und Wildtieren schützen, tragen wir dazu bei, das Risiko von Krankheitsausbrüchen zu verringern und damit die öffentliche Gesundheit zu schützen. Nicht zuletzt deswegen sind das Verständnis von Infektionen sowie die Entwicklung und Erprobung von Impfstoffen für Tiere als Grundlage für die Entwicklung von Präventionskonzepten zentrale Forschungsgegenstände an dieser Universität.
Auch der Klimawandel stellt uns als Tiermedizin vor neue Heraus-
forderungen. Beispielhaft seien die fast vergessenen Giftpflanzen erwähnt, die durch eine sich ändernde Flächennutzung wieder die Gesundheit der Tiere bedrohen. Auch beeinflusst der Temperaturanstieg die Futtermittelproduktion für unsere Nutztiere, die art- und leistungsgerecht sowie nachhaltig ernährt werden müssen, damit die gewonnenen Lebensmittel sicher und qualitativ hochwertig sind.
Die Früherkennung von Krankheiten oder Fehlentwicklungen in der Haltung von Nutztieren ist ein wesentlicher Beitrag, Wohlergehen und Gesundheit unserer Tiere zu steigern. Durch den Einsatz von sensorgestützten Untersuchungstechniken wird dies wesentlich erleichtert. Es bedarf aber spezieller Kenntnisse für die evidenzbasierte Auswertung und Interpretation der in großen Mengen anfallenden Daten. Mit dem bevorstehenden Wintersemester können vertiefte Kenntnisse hierzu im neuen Masterstudium „Digitalisierung im Tiergesundheitsmanagement“ erworben werden.
Viel Freude bei der Lektüre des aktuellen VETMED Magazins, das sich speziell mit SDG-3-Themen an unserer Universität beschäftigt!
Herausgeberin, Medieninhaberin und Verlegerin:
Veterinärmedizinische Universität
Wien und Gesellschaft der Freunde der Veterinärmedizinischen Universität Wien
1210 Wien, Veterinärplatz 1
T +43 1 25077-0
www.vetmeduni.ac.at
ISSN: 2663-1814
Blattlinie: VETMED – Das Magazin ist die offizielle Zeitschrift der Veterinärmedizinischen Universität Wien (Vetmeduni). Thematische Schwerpunkte sind in erster Linie die universitären Bereiche Forschung, Lehre und Dienstleistung sowie andere veterinärmedizinisch bzw. gesellschaftlich relevante Themen. Für namentlich gekennzeichnete Beiträge sind die jeweiligen Verfasser:innen verantwortlich.
Verantwortlich für den Inhalt: Thomas Zauner Redaktion und Produktionsleitung: Stephanie Scholz

Mitarbeiter:innen dieser
Ausgabe: Michael Bernkopf, Alexandra Eder, Clara Ginther, Corinna Gleichweit, Nina Grötschl, Astrid Kuffner, Frauke Lejeune, Franz Michlmayr, Doris Sallaberger, Stephanie Scholz, Veronika Steiner, Thomas Zauner
Redaktionsbeirat: Christine Aurich, Claudia Bieber, Tabea Breuer, Clair Firth, Christine Schwab-Schusser, Birgit Strobl, Graham Tebb
Lektorat: Laura Zechmeister
Design: Matthias Moser
Druck: Druckerei Janetschek GmbH, Brunfeldstraße 2, 3860 Heidenreichstein www.janetschek.at
Offenlegung:
Offenlegung nach § 25 Mediengesetz: Medieninhaberin (Verlegerin): Veterinärmedizinische Universität Wien, Veterinärplatz 1, 1210 Wien, Rektorin: Petra Winter
Das VETMED erscheint dreimal jährlich. Abgabe gratis.
Auflage: 6.000 Stück.
Erscheinungsort: Wien.
Bei Adressänderung wenden Sie sich bitte an: communication@ vetmeduni.ac.at
gedruckt nach den Richtlinien des Österreichischen Umweltzeichens
Druckerei Janetschek GmbH · UW-Nr. 637

Neben den essbaren Früchten des Sanddorns (Hippophae rhamnoides) wachsen noch zahlreiche andere Gehölze am Campus, die zum Naschen einladen wie Mispel (Mespilus germanica), Weiße Maulbeere (Morus alba) und Kupfer-Felsenbirne (Amelanchier lamarckii).

2 Editorial
2 Impressum Campus News
6 Kurz notiert
8 VetmedRegio
Schwerpunkt SDG 3: Gesundheit und Wohlergehen
Schwerpunkt
10 Gesundheit und Wohlergehen
Die Vetmeduni ist den UNO-Nachhaltigkeitszielen verpflichtet. Eine besondere Rolle nimmt One Health ein
14 Digitale Methoden
Das neue Projekt HOLSTEIN will Tiergesundheit durch moderne Technologie verbessern


16 Wenn die Kuh lieber im Stall bleibt als auf der Alm Studierende lernen über Tiergesundheit, Lebensmittelsicherheit und Almwirtschaft, welche Wohlfühltemperatur Kühe haben – und welchen Einfluss der Klimawandel darauf hat
18 Fitness-Check beim Stopover
In der brütenden Wüstenhitze Marokkos treffen sich Vögel und Ornitholog:innen
22 Neue Assistenzprofessur für Tierschutzwissenschaften bei Nutztieren
Borbala Foris forscht am Kreuzungspunkt von Tierwohl, (teil-)automatisierter Verhaltensanalyse und Precision
Livestock Farming
24 Anthrax von gestern: Eine Gefahr für morgen?
Wie eine bioforensische Datenbank die phylogenetische Verbreitung des Milzbranderregers erfasst
27 Karrierewege
Am Land werden Allrounder gebraucht. Birgit Dastig pendelt zwischen Bestandsbetreuung und Kleintierbehandlung

Karen Wagener untersucht die Auswirkungen von Hitzestress
Borbala Foris betreibt Forschung zum Tierwohl
Elisabeth Varga ist Spezialistin für Analytische Chemie, Lebensmittel- und Umweltanalytik

Neue Forschung zur Leptospirose bei Rindern
Unser Cover Merzouga im Südosten Marokkos ist für viele Zugvögel der erste Rastplatz nach dem Überfliegen der Wüste. Forschende der Vetmeduni nutzen diese Gelegenheit, um Vögel wie den Rotkopfwürger (Lanius senator) dabei kurz zu untersuchen.

30 Tipps fürs Tier
So funktioniert Antibiotika-Resistenztestung durch Antibiogramme und ermöglicht einen passgenauen Einsatz von Medikamenten

32 Neue Assistenzprofessur an der Klinischen Abteilung für Bestandsbetreuung bei Wiederkäuern
Hitzestress macht Kühen zu schaffen – Karen Wagener untersucht die Auswirkungen auf die Fruchtbarkeit
34 Sustainable Development Goals
Schwerpunkt Gesunde Nahrung
Studieren
36 Alumni-Splitter
37 HVU-Kommentar
38 Bild der Ausgabe
Leptospirose bei Rindern: Wie kann die Veterinärdiagnostik verbessert werden?


40 Neue Assistenzprofessur für Analytische Chemie, Lebensmittel- und Umweltanalytik
Elisabeth Varga setzt Massenspektrometrie zur Analyse von Pilz- und Algentoxinen ein
42 Bibliothek
Neuerscheinungen sowie Neuigkeiten aus unserer Universitätsbibliothek
43 Vetmeduni-Alumni
Diese und ältere Ausgaben des VETMED
Magazins online unter: www.vetmeduni.ac.at/ vetmedmagazin
Jungforscher:innen
Während der Sommerferien bot die Vetmeduni auch heuer wieder ein buntes Programm für wissbegierige Kinder. Vielen spannenden Fragen rund ums Tier gingen die Jungforscher:innen beim Floridsdorfer Ferienspiel 2023 und im Rahmen der KinderuniWien
nach. Rätselrallyes quer über den Unicampus und kindgerechte Lehrveranstaltungen machten die breite Themenvielfalt der veterinärmedizinischen Forschung und den Arbeitsalltag an der Vetmeduni für Kinder erlebbar und sorgten für Forschungsspaß.
 Text: Nina Grötschl
Text: Nina Grötschl

Neugier wecken, Wissenschaft vermitteln und erleben. Unter diesem Motto möchte der Verein ScienceCenter-Netzwerk Bewohner:innen der Wiener Randbezirke Floridsdorf und Donaustadt mit unterschiedlichen Wissenschafter:innen, die ebenfalls in diesen Grätzeln leben bzw. arbeiten, zusammenbringen. Neben zahlreichen Workshops im Vorfeld fand im Juni 2023 eine Vernetzungsveranstaltung in Floridsdorf statt. Für die Vetmeduni nahm Silvio Kau vom Institut für Morphologie teil. Er tauschte sich mit den Floridsdorfer:innen und Donaustädter:innen über aktuelle und brisante Themen wie Wissenschaftsskepsis, die Erwartung der Menschen gegenüber der Wissenschaft sowie Gender-Mainstream und Elektromobilität aus. Im Herbst 2023 soll ein kleiner, lokaler „Wissensraum“ im 21. oder 22. Bezirk als Pop-Up eröffnen und über mehrere Wochen Vermittlungsaktivitäten für die Nachbarschaft bieten. Eine weitere Gelegenheit zum gegenseitigen Austausch, zum Mitmachen und Ausprobieren.
Aktuelle Infos zu Veranstaltungen und Neuigkeiten der Vetmeduni gibt es auf allen Social-MediaKanälen.
vetmeduni.vienna
@vetmedunivienna
@vetmedunivienna

vetmedunivienna
Ausbildungen, Auszeichnungen und Preise von Angehörigen der Vetmeduni.
Felipe PenagosTabares (Institut für Physiologie, Pathophysiologie und Biophysik) zum ALIMENTARIUSWissenschaftspreis 2023.

Qendrim Zebeli (Institut für Tierernährung und Funktionelle Pflanzenstoffe) zum Bright Research and Innovation Award (BRAIN).
Cornelia Konicek (Klinische Abteilung für Interne Medizin Kleintiere) zum Diplomate des European College of Zoological Medicine (avian, ECZM).
Michaela Gumpenberger zur Ernennung zum Associate Member des European College of Veterinary Diagnostic Imaging (ECVDI).
Eine Übersicht über unsere Veranstaltungen wie Antrittsvorlesungen, Tagungen sowie akademische Feiern finden Sie hier:
Immer aktuell informiert
Niederösterreich
Begeisterung für die Welt der Wissenschaft wecken und aktuelle Forschungen für Jugendliche greifbar und erlebbar machen, das hat sich die Science Academy Niederösterreich zum Ziel gesetzt. Das Besondere: Die Vetmeduni ist heuer erstmals mit einem eigenen Lehrgang Teil des Programms. „Das Tier und Wir – Wie Tierwohl, Lebensmittelsicherheit und Klimaschutz zusammenhängen“ ist nicht nur Titel des Lehrgangs, sondern gibt auch einen ersten Eindruck über die Themenvielfalt, die Wissenschafter:innen der Vetmeduni bei der Science Academy Niederösterreich abdecken. Ob Haltungs- und Ernährungsbedürfnisse von Nutztieren wie Rinder und Schweine, Pferdegesundheit oder der Domestikationsprozess vom Wolf zum Hund – die Jugendlichen lernen bei diesem einmaligen außerschulischen Programm in 15 verschiedenen Workshops das breite Feld der Tiermedizin und Lebensmittelsicherheit kennen. Weitere aktuelle Themenblöcke sind Klimaschutz, Ethik und Tierwohl, der Einsatz von Antibiotika in der Tiermedizin und die Rückverfolgbarkeit, Qualität und Sicherheit von Lebensmitteln. Neben Vorträgen können die Jugendlichen vor allem während der Praxistage im Sommer am Campus Tulln und auf der VetFarm in Pottenstein selbst aktiv werden und zum Beispiel Futter mischen oder sich in der Käsemacherei (auch vegan) versuchen. Zusätzlich gibt es eine Exkursion zur Österreichischen Vogelwarte in Seebarn. Das Programm ist also so vielfältig und abwechslungsreich wie die Tiermedizin selbst und gibt den Teilnehmer:innen einzigartige Einblicke in die Praxis der Nutztierhaltung und den Forschungsalltag.
„Das Tier und Wir“ ist einer von acht Lehrgängen der Science Academy Niederösterreich aus unterschiedlichen akademischen Disziplinen.
Für wen: Jugendliche zwischen 14 und 16 Jahren
Was/Wann: 15 Workshops von Februar 2024 bis Juni 2025 sowie eine betreute Sommerwoche
Start: Kick-off-Wochenende im Jänner 2024 Kosten: 240 Euro
Bewerbungsfrist bis 15. Oktober 2023

„Das Tier und Wir“ bei der Science
Niederösterreich
Die weltberühmten Lipizzaner aus der Nähe beobachten und alles darüber erfahren, was sie brauchen, um gesund zu bleiben – dieser Traum wurde für 30 Kinder Mitte Juli im Rahmen der KinderUniGraz wahr.
Bereits zum zweiten Mal konnte diese Exkursion von der KinderUniGraz dank der Kooperation zwischen dem Lipizzanergestüt Piber und der Veterinärmedizinischen Universität Wien angeboten werden. Und zwar mit Erfolg: Der Workshop war wie im letzten Jahr binnen Minuten ausgebucht. Die Vorfreude und Begeisterung war auch vor Ort spürbar: Es wurde gehämmert, am frischen Heu geschnuppert, versucht, das richtige Pferdetraben nachzuahmen und viel gelacht über die Geräuschkulisse von Verdauungsproblemen beim Pferd. In vier praktischen und theoretischen Workshops konnten die Kinder unter anderem die eigene Kraft beim Hufeschmieden testen, gesundes Pferdefutter selbst anmischen, den Gang von Pferden analysieren und alles über die richtige Behandlung von Koliken erfahren. Die Pferdeexpert:innen und Veterinärmediziner:innen der Vetmeduni und der Spanischen Hofreitschule teilten ihr Fachwissen und beantworteten mit spannenden Anekdoten aus ihrem Berufsalltag alle Fragen zum richtigen Umgang mit den weltberühmten Reittieren. Das Besondere: Neben dem direkten Kontakt mit den Tieren lernten die Kinder spielerisch den verantwortungsvollen Umgang mit Pferden kennen und konnten so in das Berufsbild Tiermedizin und Tierpflege vor Ort hineinschnuppern.
Anschließend an den Erfolg vom letzten Jahr konnten auch heuer wieder interessierte Jugendliche zwischen 16 und 19 Jahren bei der Summer School VetINNSights spannende Einblicke in das Studium und Berufsfeld Tiermedizin gewinnen.
Am 10. Juli startete die diesjährige Summer School VetINNSights in Tirol. Neben verschiedenen Fachvorträgen wurden die Jugendlichen auch selbst aktiv: Sie untersuchten im Stall Kühe und lernten, wie man den Pansen richtig abhört, schauten in der Landwirtschaftlichen Landeslehranstalt (HBLFA) Rotholz und in einer Sennerei im Pitztal bei der Käseproduktion zu und sahen bei einer Exkursion zum Tiroler Steinbockzentrum die alpinen Kletterkünstler aus der Nähe. Informationen, Probetests und praktische Tipps für das Aufnahmeverfahren an der Veterinärmedizinischen Universität Wien rundeten die fünftägige Summer School ab und gaben realistische Einblicke, was es braucht, um selbst Tierärztin/Tierarzt zu werden. Die Summer School VetINNSights wurde bereits zum zweiten Mal von der Vetmeduni gemeinsam mit dem Land Tirol im Rahmen von VetmedRegio organisiert. VetmedRegio leistet österreichweit mit zahlreichen Projekten und Veranstaltungen einen wichtigen Beitrag dazu, den Stellenwert der Tiermedizin in der Gesellschaft zu stärken und die veterinärmedizinische Versorgung von ländlichen Regionen im Nutztierbereich zu verbessern.



Dass Gesundheit das höchste Gut und damit ein wesentlicher Aspekt unseres Wohlergehens ist, ist wohl gerade angesichts des aktuellen Klimawandels besonders ins kollektive Bewusstsein gerückt. „Gesundheit und Wohlergehen“ heißt auch das Nachhaltigkeitsziel 3 der UNO. Die Vetmeduni ist diesem UNO-Ziel verpflichtet und forscht, lehrt und praktiziert zum Wohle der menschlichen und tierischen Gesundheit. Eine besondere Rolle in der Erreichung des Nachhaltigkeitsziels kommt dabei dem One-Health-Ansatz zu.
 Text: Veronika Steiner
Text: Veronika Steiner
SDG
Schwerpunkte der Vetmeduni
2020 + 2023
SDG 3
„Gesundheit und Wohlergehen“
2021 + 2024
SDG 2
„Kein Hunger“

Die Herausforderungen unserer Zeit sind vielfältig: Der Klimawandel verändert nicht nur den Lebensraum von Menschen, Nutz- und Wildtieren, sondern führt durch Extremtemperaturen und Großwetterereignisse immer öfter auch zu Wassermangel und Futtermittelknappheit, was sich auf die lokale und globale Lebensmittelsicherheit auswirkt. Gleichzeitig sorgt der Temperaturanstieg dafür, dass zahlreiche neue Insektenarten in Europa ankommen, wodurch die Gefahr für die globale Verbreitung von Zoonosen und vektorbasierten Krankheiten wächst. All diese Faktoren beschäftigen nicht nur die Politik, Landwirtschaft und die Humanmedizin, sondern auch und vor allem die Veterinärmedizin.
Nachhaltige Entwicklung als globales Anliegen
2022 + 2025
SDG 15

„Leben an Land“
PhD-Programm
PhD-One-HealthProgramm
Die Vetmeduni startet im Herbst/Winter 2023/2024
ihr One-Health-PhD-Programm. Es richtet sich an Studierende, die an der Schnittstelle zwischen tierischer und menschlicher Gesundheit, Lebensmittelsicherheit und ökologischer Nachhaltigkeit forschen wollen.
Seit 2016 arbeiten weltweit alle Länder daran, im Zuge der sogenannten Agenda 2030 insgesamt 17 Ziele für nachhaltige Entwicklung (Sustainable Development Goals, SDGs) zu erreichen. Die Förderung von Frieden und Wohlstand, der Schutz unseres Planeten und die Bekämpfung von Armut und Ungleichheit sind der gemeinsame Nenner aller Ziele. Auch die Veterinärmedizinische Universität Wien trägt mit ihren Kernaufgaben Forschung und Lehre, aber auch im Sinne der „Third Mission“ mit ihren Kommunikationsmaßnahmen zur Erreichung der Entwicklungsziele bei. Im Zuge ihrer Nachhaltigkeitsoffensive wurden drei Entwicklungsziele ausgewählt, die als jährlicher Schwerpunkt bearbeitet werden. Heuer liegt der Fokus zum zweiten Mal auf dem SDG 3 „Gesundheit und Wohlergehen“.
Die Arbeits- und Forschungsfelder an der Vetmeduni sind so vielfältig wie die globalen Herausforderungen und die Aspekte von „Gesundheit und Wohlergehen“. Im Zuge der Nachhaltigkeitskommunikation zum SDG 3 wurden folgende thematische Schwerpunkte

gesetzt, die mittels Forschungsbeiträgen, Lehrveranstaltungen, Diskussionsveranstaltungen, Artikeln, Social-Media-Kampagnen etc. einer möglichst breiten Öffentlichkeit zugänglich gemacht werden: Den Anfang machte im ersten Quartal „Gesundes Land“, dann folgten „Gesunde Nahrung“, „Gesunde Tiere“ und abschließend im vierten Quartal das Thema „Was ist überhaupt gesund?“, wo auf die Grundlagenforschung rund um Gesundheit eingegangen wird. Ein Auszug dieser Themenvielfalt findet sich auch in der vorliegenden Schwerpunktausgabe.
Allen Themen gemeinsam ist die Frage, was die Veterinärmedizin mit ihrer Arbeit dazu beitragen kann, das Entwicklungsziel „Gesundheit und Wohlergehen“ zu erreichen.
Wessen Gesundheit?
One Health als holistische Antwort
Hand in Hand geht damit die Frage einher, um wessen Gesundheit es in den globalen Bemühungen gehen soll. Eine Antwort gibt der One-Health-Ansatz, der die Gesundheit von Menschen, Tieren und Umwelt zusammen betrachtet und als gleichwertig erachtet. Für diesen holistischen Paradigmenwechsel braucht es ein interdisziplinäres Vorgehen. Dem wurde erstmals 2004 im Zuge der sogenannten Manhattan-Prinzipien Rechnung getragen, als von der Wildlife Conservation Society (WCS) und der Rockefeller University internationale Expert:innen aus verschiedenen Disziplinen zwölf Empfehlungen zur Vorbeugung von Epidemien und Tierseuchen und zur Erhaltung des Ökosystems und der Artenvielfalt aussprachen. 2019 verabschiedeten Expert:innen bei der vom Deutschen Auswärtigen Amt und der WCS organisierten „One Planet, One Health, One Future“-Konferenz die sogenannten Berliner Prinzipien. Ein Prinzip betrifft die Forderung, „adaptive, ganzheitliche und zukunftsweisende Ansätze zu entwickeln zur Erkennung, Prävention, Überwachung, Kontrolle und Abschwächung neu auftretender/wiederauflebender Krank-
heiten, und zur Verschärfung übertragbarer und nichtübertragbarer Krankheiten, die die komplexen Zusammenhänge zwischen Arten, Ökosystemen und der menschlichen Gesellschaft einbeziehen“ (Prinzip 5, Berliner Prinzipien). Dem leistet die Veterinärmedizinische Universität Wien in ihrer Lehre und Forschung bereits Folge.




An der Vetmeduni ist das One-Health-Prinzip also schon länger bekannt. Das komplexe Zusammenspiel von menschlicher und tierischer Gesundheit sowie von Umweltfaktoren ist Teil der Lehre und der Forschung. Den holistischen Ansatz in die eigene Forschung noch stärker einzubinden, das ist das Ziel des neu geschaffenen interdisziplinären One-Health-PhD-Programms, das im Wintersemester 2023/2024 erstmals startet. Die Studierenden erforschen die Zusammenhänge zwischen Gesundheit, Lebensmittelsicherheit und ökologischer Nachhaltigkeit. Die Themen der PhD-Stellen geben einen guten Eindruck von der Vielfalt der globalen Herausforderungen, denen sich die Veterinärmedizin mit ihrer Arbeit stellt. Durch die Anwendung von One-Health-Konzepten soll die Gesundheit von Menschen, Tieren und Ökosystemen gleichermaßen unterstützt werden. Der breit gefächerte Lehrplan umfasst deshalb neben Epidemiologie, Infektionskrankheiten, nichtübertragbaren Krankheiten, Mikrobiologie, Datenwissenschaft und Lebensmittelsicherheit auch Ökologie und Naturschutzmedizin. Die Mitglieder des Lehrkörpers sind Expert:innen auf ihrem Gebiet und bieten den Studierenden eine hochwertige Ausbildung und praktische Forschungserfahrung.


Die Begutachtung der eingereichten Projekte erfolgte durch eine internationale Fachjury, die vom Wiener Wissenschafts-, Forschungsund Technologiefonds WWTF ausgewählt wurde.











Die Förderung von Frieden und Wohlstand, der Schutz unseres Planeten und die Bekämpfung von Armut und Ungleichheit sind der gemeinsame Nenner aller Nachhaltigkeitsziele.
Prof. Peter M. Roth, Leiter des Instituts für Computational Medicine der Vetmeduni, im Interview zur Rolle des neuen Forschungsprojekts HOLSTEIN mit dem Ziel, die Tiergesundheit mittels moderner Technologien zu verbessern.
VETMED: Vielfältige Lösungen für die Überwachung der Tiergesundheit sind bereits auf dem Markt vorhanden, aber die Digitalisierung im Stall ist noch nicht überall angekommen. Woran liegt das Ihrer Meinung nach?
Peter M. Roth: Die Gründe hierzu sind mannigfaltig. Einerseits gibt es eine gewisse Skepsis, was neue Technologien anbelangt. Hier sind Best-Practice-Beispiele notwendig, anhand derer gezeigt werden kann, dass technologische Innovation von Vorteil ist. Andererseits ist moderne Technologie oft sehr kostenintensiv, weshalb diese oft nur bei Neu- oder Umbauten Einzug findet. Und schlussendlich ist oft leider nicht bekannt, welche Daten ohnehin bereits erhoben und für unterschiedliche Aspekte genutzt werden könnten. Genau hier setzt HOLSTEIN an.
Was genau wird im Projekt HOLSTEIN erforscht?
Roth: HOLSTEIN ist ein sprechender Name und steht als Akronym für „Holistischer Ansatz zur nachhaltigen Sicherstellung der Nutztiergesundheit in Niederösterreich“. Holistisch bedeutet in diesem Zusammenhang, dass präventive und kurative Ansätze parallel verfolgt werden. Insbesondere ist
die Kernfrage in HOLSTEIN, ob und welche Daten, wie zum Beispiel via Melkroboter oder allgemeine Gesundheitsdaten der Tiere, im täglichen landwirtschaftlichen Betrieb erhoben werden und wie diese auch für die Nutztiermedizin verwendet werden können.
Inwiefern soll die Tiergesundheit im Nutztierbereich von dem Projekt profitieren?
Roth: Das Projekt HOLSTEIN ist in ein größeres strategisches Programm, eHealth@ vetmed, eingebettet, in dem neben technischen und medizinischen Fragestellungen auch sozioökonomische und rechtliche Aspekte evaluiert werden. Es hat sich ins-
Steckbrief
Peter M. RothFachgebiet
Data Science, Machine
Learning und Computer
Vision
Positionsbeschreibung
Leiter des Instituts für Computational Medicine & wissenschaftlicher

Leiter des Programms
„eHealth@vetmed“
„Durch
können Ressourcen besser und effizienter eingesetzt werden.“
besondere gezeigt, dass zur Sicherstellung der Qualität der Versorgung mehr als nur ein Vermittlungssystem und die Zurverfügungstellung von Daten erforderlich ist. Vielmehr muss Information sinnvoll erfasst, ausgewertet und kommuniziert werden. So bildet HOLSTEIN einen wesentlichen Meilenstein, um das Ziel einer modernen Nutztiermedizin gewährleisten zu können.
Bei den vielen bereits existierenden Systemen auf dem Markt – wie wollen Sie erreichen, dass HOLSTEIN die beste Lösung hervorbringt?
Roth: HOLSTEIN verfolgt andere Ziele als die bereits am Markt vorhandenen Systeme. Es geht weder um reine Datenerfassung noch um eine Kommunikationslösung. Vielmehr sollen diese Aspekte kombiniert werden, um die richtigen Informationen in geeigneter Form zur Verfügung stellen zu können.
Was sind die größten Herausforderungen?
Roth: Die größte Herausforderung ist die Skepsis, die uns bei diesem Thema von mehreren Seiten entgegenschlägt. Neben technologischen Entwicklungen ist es daher auch wichtig, diese im Detail zu evaluieren und deren praktische Vorteile zu zeigen.
Welche Vorteile sehen Sie in digitalen Methoden in der Tiermedizin?
Roth: Der Faktor Mensch wird in der Tiermedizin auch in Zukunft entscheidend sein. Behandlungen oder fundierte Diagnosen können nur durch geschulte Veterinär:innen erfolgen. Vorteile ergeben sich jedoch aus dem permanenten Monitoring (Langzeitbeobachtungen), einer besseren und strukturierten Aufbereitung bzw. Darstellung von medizinischen Daten oder einer Reduktion von administrativen Aufgaben. Dadurch bleibt einerseits mehr Zeit für die eigentliche Versorgung und Behandlung von Tieren; andererseits können vorhandene Ressourcen besser und effizienter eingesetzt werden.
Können Sie schon erste Ergebnisse zeigen?
Roth: Die ersten Prototypen werden gerade an der VetFarm Kremesberg implementiert und wurden im Rahmen des Forschungsfests des Landes Niederösterreich im September einer breiteren Öffentlichkeit präsentiert. Dies ist insbesondere wichtig, um auch einem nichtwissenschaftlichen Publikum das Thema Tiergesundheit und Nahrungsmittelsicherheit näherbringen zu können.
Werden diese Aspekte auch in Studium und Lehre abgebildet?
Roth: Noch nicht! Aber mit dem im Wintersemester 2023/24 startenden Masterstudium „Digitalisierung im Tiergesundheitsmanagement (Precision Animal Health)“ findet sich das Thema Digitalisierung auch an der Vetmeduni in der Lehre wieder. Mittelfristig gehe ich davon aus, dass sich Inhalte aus dem Masterstudium auch im Curriculum der Veterinärmedizin wiederfinden werden.

Woher kommt das Herzblut, das Sie in dieses Projekt stecken?
Roth: Ich bin selbst auf einem Bauernhof zwischen Tieren aufgewachsen, der sich im Laufe der Zeit verändert hat. Parallel dazu ist recht früh das Interesse an der Informatik erwacht. In diesem Projekt, oder noch allgemeiner in meiner aktuellen Position, kann ich diese beiden Interessen perfekt miteinander verbinden.
Glücklich macht mich … … das bzw. dieses akademische Umfeld.
Ausgleich finde ich … … auf meinem Bauernhof in Mooskirchen (sofern mir Borkenkäfer nicht das Leben schwer machen).
Mein Tipp an alle, die Data Scientist werden möchten … … ist vermutlich nicht die populärste Antwort, aber die Nase tief in Statistikbücher stecken und versuchen, die Schönheit und den praktischen Nutzen von Mathematik zu erfassen …
Das neue Masterstudium konzentriert sich auf das Management von Tiergesundheit und Digitalisierung. Das Studium ist für jene Studierende ausgelegt, die Interesse daran haben, sich an der Schnittstelle zwischen Tiermedizin, Tierhaltung, Tierproduktion und modernen informationsgestützten Technologien weiterzubilden.
Mein Lieblingsort an der Vetmeduni ist … … eigentlich mein Büro, in dem ich nicht nur sehr viele fruchtbringende Diskussionen habe, sondern auch den botanischen Garten und eigentlich den „ganzen Campus“ gut im Blick habe.
Alle Informationen zu eHealth@vetmed unter: www.vetmeduni.ac.at/ ehealth
Hitzestress, Wassermangel und der Anstieg von vektorübertragenen Infektionen sind Auswirkungen des KLIMAWANDELS auf Österreichs Almwirtschaft, die jetzt schon sichtbar sind. Was das für die Arbeit von angehenden Veterinärmediziner:innen bedeuten wird, ist Thema des Seminars „Tiergesundheit und Almwirtschaft im Zeichen des Klimawandels“, das gerade im neuen Vertiefungsmodul „Tiergesundheit, Lebensmittelsicherheit und Almwirtschaft“ in Innsbruck stattfindet.
Text: Veronika Steiner • Fotos: Lorenz Khol/Vetmeduni (S. 16), Michael Bernkopf/Vetmeduni (S. 17)
Grasende Kühe vor der beeindruckenden Kulisse der Alpen, in der Ferne das Geplätscher einer Quelle – diese romantische Vorstellung von Almwirtschaft deckt sich immer weniger mit der Realität. Stattdessen sieht man Kühe, die sich im Sommer schon um 9 Uhr Früh am Weg zurück vor der Stalltür drängen. Kein Wunder, liegt doch die Wohlfühltemperatur einer Kuh bei zirka 15 Grad Celsius. „Alles über 25 Grad ist für eine Kuh schon nicht mehr erträglich“, erklärt Clair Firth (Abteilung für Öffentliches Veterinärwesen und Epidemiologie), die das Seminar „Tiergesundheit und Almwirtschaft im Zeichen des Klimawandels“ leitet. Dass bei den immer heißer werdenden Sommern Hitzestress für die Tiere vorprogrammiert ist, liegt auf der Hand. Weniger bekannt ist, dass dieser Hitzestress auch direkte Auswirkungen auf die Fruchtbarkeit und die Milchproduktion der Kühe hat.
Wissen um Auswirkungen des
Landwirt:innen aufzuklären und beratend zu unterstützen, wie man Rindern das Leben in den heißen Sommern erträglicher machen
Der bunte Mix aus transdisziplinären Theorieeinheiten (so gibt es zum Beispiel auch Seminareinheiten der Uni Innsbruck), problemorientiertem Lernen, sowie praktischen Rotationen, bei denen die Studierenden erfahrene Veterinärmediziner:innen auf ihren Einsätzen bei Landwirt:innen begleiten, zeichnen das Vertiefungsmodul unter der Leitung von Lorenz Khol aus.

kann, sieht Clair Firth als wesentliche Aufgabe von Veterinärmediziner:innen. Dass ihre Beratungsfunktion in Bezug auf Auswirkungen der Erderwärmung immer wichtiger wird, ist auch den angehenden Tierärztinnen Anna Malle und Viktoria Mayrhofer-Wiesner bewusst: „Um Landwirt:innen gut beraten und damit auch etwas für die Tiergesundheit bewirken zu können, muss man sich in Zukunft als Veterinärmediziner:in auch mit dem Klimawandel auskennen“, sind sich die beiden einig. Beide wählten für ihren dritten Studienabschnitt das neu angelaufene Vertiefungsmodul „Tiergesundheit, Lebensmittelsicherheit und Almwirtschaft“, das in Innsbruck abgehalten wird.
Vom Hörsaal in den Stall – das kommt auch bei den Studierenden gut an: „Ich finde das Zusammenspiel von Wissenschaft und Praxis super. Das ist genau die richtige Mischung für die Thematik“, erzählt Anna Malle, die das Modul als Ergänzung zu ihrem Hauptmodul Pferdemedizin gewählt hat.
Auch ihre Kommilitonin Viktoria MayrhoferWiesner (Hauptmodul Kleintiermedizin) beschreibt das Wiederkäuermodul als „Horizonterweiterung“, von dem sie „unglaublich viel mitgenommen“ hat.
„Es hat mich überrascht, wie sehr uns die Nutztiere die Auswirkungen des Klimwandels schon zeigen“, erzählt Anna Malle. „Wir sehen die Auswirkungen jetzt und wir sehen sie schon länger“, ergänzt Clair Firth. Die Zusammenhänge sind vielschichtig: Der erwähnte Hitzestress äußert sich auch in einem erhöhten Wasserbedarf bei den Tieren. Gerade der wird auf den Almen aber zum Problem, gibt es doch keine Wasserleitungen, sondern werden die meisten Viehtränken aus Quellwasser gespeist. Dieses wird durch den Schneemangel knapp bzw. werden die Wasserspeicher nicht ausreichend aufgefüllt. Firth berichtet zum Beispiel von Rinderherden in Vorarlberg, die auf Grund des Wassermangels frühzeitig wieder ins Tal getrieben wurden. Da gibt es aber oft nicht genug Futtermittel, hatten die Landwirt:innen doch mit der Alm als Futterquelle im Sommer gerechnet.
Zecken im November
Ein weiteres Beispiel aus der Praxis betrifft den Anstieg von vektorübertragenen Infektionen. „In den Bergen hatte ich den Fall, dass eine Kuh auf Grund eines Zeckenbisses erkrankt ist. Und zwar im November!“, beschreibt Firth. Es zeichnet sich ab, dass die Parasiten früher kommen und länger aktiv sind. Das betrifft auch die Übertragung mittels unterschiedlicher Insekten von ehemals als tropisch geltenden Krankheiten, wie Blauzungenkrankheit, West-Nil-Fieber oder Afrikanische Schweinepest. „Es ist davon auszugehen, dass durch Insekten übertragene Krankheiten und Zoonosen durch den Klimawandel noch weiter zunehmen. Hier sehe ich auch den größten Handlungsbedarf in meiner beruflichen Zukunft als Veterinärmedizinerin: Jetzt schon vorausschauend mitbedenken, welche Krankheiten durch Parasiten und andere Insekten auch zu uns kommen könnten“, sagt Viktoria Mayrhofer-Wiesner.
Der Blick in die Zukunft: Yes, we can?
In die Zukunft sieht sie trotzdem eher neutral: „Es kommen zwar große Probleme auf uns zu, aber es arbeiten global so viele Menschen
an Lösungen, dass auch jetzt schon viel passiert“, sagt sie. Als „gesunde Mischung aus Realismus und Optimismus“ beschreibt Clair Firth die Stimmung in ihrem Seminar, als es darum ging, welchen Handlungsspielraum die angehenden Tierärzt:innen im Hinblick auf die angesprochenen Herausforderungen haben werden. „Die Studierenden sind sich bewusst, dass der Klimawandel und seine Auswirkungen uns alle noch weiter beschäftigen und viel verändern wird. Sie sehen großen Handlungsbedarf in der Politik und bei der Industrie. Gleichzeitig war es schön zu sehen, dass sie sich selbst und ihrem Berufsstand in Zusammenarbeit mit den Landwirt:innen einen großen Gestaltungsspielraum zutrauen“, so Firth.
Von der oft zitierten Klimaangst (climate anxiety) war in Clair Firths Seminar nicht viel zu spüren. Auf die Frage, ob und welche klimabezogenen Herausforderungen die Tiermedizin beeinflussen kann, stapelten sich die bunten Klebenotizen auf der mit „Ja“ betitelten Pinnwand. Die Behandlung von vektorübertragenen Krankheiten, der medikamentöse Schutz vor Parasiten, das Monitoring von ehemals tropischen Krankheiten und die Prävention von Hitzestress sind einige Themen, die genannt wurden. Auch Anna Malle ist optimistisch: „Der Klimawandel wird viele Probleme bringen, aber gemeinsam mit den Landwirt:innen werden einige Probleme bestimmt zu bewältigen sein!“, ist sie sich sicher.
Viktoria MayrhoferWiesner (links im Bild) und Anna Malle (rechts) wählten das Vertiefungsmodul „Tiergesundheit, Lebensmittelsicherheit und Almwirtschaft“ in ihrem dritten Studienabschnitt.
Es war schön zu sehen, dass die Studierenden sich selbst und ihrem Berufsstand in Zusammenarbeit mit den Landwirt:innen einen großen Gestaltungsspielraum in Sachen Klimawandel zutrauen. CLAIR

Der erste Rastplatz nach der Sahara heißt Merzouga. Viele ZUGVÖGEL tanken hier nach der Wüstenquerung auf ihrem Rückweg nach Europa Kraft. Im Rahmen des One-HealthPhD-Programms wird eine Doktorandin ab Frühjahr 2024 genauer untersuchen, ob und wie eine Parasitenbelastung die Fitness wandernder Vogelarten beeinflusst.

Text: Astrid Kuffner • Fotos: Sara Ricci/Vetmeduni, Ivan Maggini/Vetmeduni
Vierzig bis fünfzig europäische Singvogelarten überfliegen jedes Jahr die Sahara auf dem Weg in ihre afrikanischen Winterquartiere. Im Frühjahr, zwischen März und Mai, kehren Zugvögel wie Nachtigall, Fitis oder Rotkopfwürger aus der Sahelzone, dem tropischen West- oder Südafrika, zurück. Der erste Stopover nach dem Überfliegen der Wüste ist für viele Arten auf ihren bewährten Flugrouten Merzouga im Südosten Marokkos ein inzwischen trockengefallener See mit seinen umgebenden Sträuchern und Tamarisken. Ein Hotspot für Vogelfreund:innen und Vogelforscher:innen, die hier gleichermaßen auf der Lauer liegen.
Die Forschenden nutzen die Gelegenheit, die Zugvögel beim Stopover kurz zu untersuchen. Im Projekt „Ökophysiologie von wandernden Singvögeln bei der Rast nach der Wüste“, das für das One-Health-PhD-Programm der Vetmeduni ausgesucht wurde, wird erforscht, wie Parasitenbelastung und Zugverhalten zusammenhängen. Dafür wird eine Doktorandin die Vögel ab Frühjahr 2024 in ihrem natürlichen Verhalten beobachten, mit standardisierten Methoden fangen, vermessen, beringen, eine Blutprobe nehmen und ein paar Minuten später wieder freilassen.
„Wir wissen, dass die Hälfte der Zugvögel Parasiten in sich trägt“, erklärt Ivan Maggini, Ornithologie am Konrad-Lorenz-Institut für Vergleichende Verhaltensforschung. Er ist einer der beiden Betreuer des Projekts. Da sich die Wildvögel meist über Jahrtausende an „ihre“ Parasiten angepasst haben, erkranken sie nicht offensichtlich. Eine spezielle Gruppe sind die aviären Hämosporidien (auch Vogelmalaria genannt), die über Insekten übertragen werden. Viele dieser Erreger haben sich auf eine einzige Vogelart spezialisiert. Zur Erkrankung oder zu Todesfällen kommt es also nur, wenn nichtangepasste Spezies befallen werden.
„Pinguine sind sehr vulnerabel“, erklärt Herbert Weißenböck vom Institut für Pathologie der Vetmeduni.
Kurze Pause: Nach der anstrengenden Saharaquerung sind europäische Zugvögel in Merzouga gut zu beobachten (im Bild ein Blauwangenspint). Wer ihre Fitness messen möchte, hält die Tiere besser nicht lange damit auf.

Nicht nur Sand: Merzouga liegt zu Füßen der Sanddünen des Erg Chebbi (oben). Der einstige See ist verdunstet, aber Tamarisken und die Gärten von Hotels bieten dem Mittelmeer-Steinschmätzer (unten) und der Weissbart-Grasmücke (rechts) Schatten und Nahrung beim Stopover.

Für die Geflügelhaltung in Mitteleuropa „stellen die hier vorkommenden Vogelmalariaerreger kein Problem dar“, gibt er Entwarnung. Ein Forschungsziel ist, in Merzouga einen besseren Einblick zu bekommen, welche Parasiten wandernde Arten aus ihren Winterquartieren mitbringen und in sich tragen. Ivan Maggini: „Wir wollen zudem verstehen, ob und wie ihr Zugverhalten dadurch beeinträchtigt wird. Im Frühjahr müssen sie so schnell wie möglich ziehen, um rechtzeitig ihr Territorium zu besetzen. Weiterführend wollen wir wissen, ob sie ihre Strategien anpassen können oder müssen, wenn sie weniger Wasser zur Verfügung haben oder der Rastplatz verloren geht.“
Oase und Wien
Am Rande der Wüste wird von kurz vor Sonnenaufgang bis mittags beobachtet und geforscht. Dann wird es brütend heiß. Mensch und Tier flüchten in den Schatten. Die zweite Schicht geht von 16 Uhr bis Sonnenuntergang. Dann wird es stockfinster. An anderen Standorten wurde bereits nachgewiesen, dass die Parasitenbelastung einen Einfluss auf die Regenerationsdauer der Vögel hat. Mit kleinen Geräten, vergleichbar der Blutzuckermessung, werden im Feld Metaboliten im Blut bestimmt und so ein Bild vom Ernährungszustand der Tiere gewonnen. Die Blutproben zur Bestimmung von Menge und Art der Parasiten werden auf Objektträgern vorbereitet und im Labor von Herbert Weißenböck in Wien bestimmt. „Am Institut für Pathologie beschäftigen wir uns seit mehr als einem Jahrzehnt mit diesem Thema. Unsere Kernkompetenzen sind das Barcoding, also die molekulare Identifikation verschiedener Entwicklungslinien aviärer Hämosporidien, sowie der Nachweis von Entwicklungsstadien der Parasiten in Gewebeproben. Damit konnten wir vielfach zeigen, dass manche dieser Erreger für den Vogel nicht so harmlos sind, wie von manchen Wissenschafter:innen bisher angenommen.“
Merzouga ist interessant, weil die wandernden Singvögel hier gerade eine Etappe von 2.000 Kilometern hinter sich gebracht haben und Kraft tanken für die Etappe über das Mittelmeer. Solche Rastgebiete sind unverzichtbar für die Wildtiere und durch die zunehmende Erwärmung und Wüstenausbreitung gefährdet: „Wir wollen letztlich auch zeigen, dass viele Arten diese Gebiete nutzen und sie bewahrt werden müssen“, so Ivan Maggini. Mit seinen Dünen ist der Ort auch touristisch interessant und so werden immer mehr Unterkünfte errichtet, deren Gärten aktuell das Nahrungsangebot für die Zugvögel bereichern. Noch ist die Balance aus Attraktivität und Ruhe intakt.

Uns interessiert, ob die Zugvögel ihre Strategien anpassen können, wenn sie weniger Wasser zur Verfügung haben oder der Rastplatz verloren geht und ob ein Parsitenbefall sie unnötig aufhält.
IVAN MAGGINI
BORBALA FORIS, neue Assistenzprofessorin für Tierschutzwissenschaften bei Nutztieren, forscht am Kreuzungspunkt von Tierwohl, (teil-)automatisierter Verhaltensanalyse und Precision Livestock Farming. Sie begreift den Stall als soziales Netzwerk und möchte unter anderem mit einer smarten Bürste positives Verhalten als Ausdruck von Wohlbefinden in den Blick nehmen.
Bernkopf/VetmeduniMonitoring: Der Stall als soziales Netzwerk
Das Welfare Quality Network ist eine Gemeinschaftsinitiative ehemaliger Partner des Welfare Quality®-Projekts. Das Welfare Quality Network konzentriert sich auf den wissenschaftlichen Austausch und Aktivitäten, um zur Weiterentwicklung der Welfare Quality®Tierwohl-Bewertungssysteme beizutragen.
Wenn Rinder in einer Herde nicht miteinander können, wird das offenkundig. Da wird gerempelt, geschubst und gestoßen. Wenn die Milchleistung zurückgeht, läuten im Betrieb immer die Alarmglocken. Aber wie zeigt sich gute Stimmung und Wohlbefinden im Stall? Borbala Foris, seit September 2023 neue Assistenzprofessorin für Tierschutzwissenschaften bei Nutztieren, setzt beim Tierwohl-Monitoring auf die (teil-)automatisierte Beobachtung und Datenauswertung von Individuum und Bestand mittels Precision Livestock Farming. Sie will wissen, wie sich ein glückliches Rind in den nach Produktionskriterien ausgerichteten Herden verhält und wie das am besten beobachtet und gemessen werden kann. Aus dem Verhalten von Einzeltieren will sie validierte Indikatoren und Normalwerte bestimmen und mit der Auswertung von Bestandsdaten Warnzeichen sichtbar machen, sodass Tierhalter:innen früh eingreifen können. Dazu nimmt sie neben essenziellen auch nichtlebensnotwendige Verhaltensweisen in den Blick. Zum Überleben müssen Kühe liegen, stehen, fressen und trinken. Als Indikator für schiere Lebensfreude hat Borbala Foris zum Beispiel die Nutzung von Bürsten im Verdacht. Eine smarte Bürste im Stall kann erkennen, welches Tier sie wie lange nutzt.
Erstmals kam die 35-jährige Ungarin 2010 mit den Welfare Quality® Assessment Protocols in Kontakt, die ein Jahr davor von einem Zusammenschluss europäischer Universitäten und Forschenden herausgegeben wurden. Sie war sofort begeistert von der Möglichkeit, „mit einer Methode nicht nur Einzeltiere zu behandeln, sondern präventiv und auf Betriebsebene viele Tiere gleichzeitig, wenn ich neue Methoden fürs Monitoring entwickle“. Während ihres Studiums an der Veterinärmedizinischen Universität in Budapest (Ungarn) absolvierte sie Praktika und besuchte für die Diplomarbeit Betriebe unterschiedlicher Größe in Ungarn und Deutschland. Dort sammelte sie praxisrelevante Informationen zur Verhaltensbeobachtung und Analyse. Dabei kam ihr die Rolle als Forscherin, im Vergleich zu einer Auditorin, sehr gelegen: „Ich habe immer gesagt, dass die Protokolle nicht endgültig sind und ich komme, um mir die Tiere im Betrieb anzusehen und die Handbücher zu verbessern. Es gab Austausch auf Augenhöhe darüber, was ich messe und warum, die Bauern und Bäuerinnen haben mir Feedback gegeben, was sie beobachten und ob meine Messungen aus ihrer Sicht sinnvoll sind. Das ist ganz wichtig, weil wir etwas entwickeln wollen, das ihnen in der Praxis weiterhilft.“
2015 vertiefte sie die Bewertung der Variationen von individuellem und Gruppenverhalten in Milchkühen – von der Persönlichkeit hin zum sozialen Netzwerk Stall. In ihrem PhD
Text: Astrid Kuffner • Fotos: Michaelam Leibniz-Institut für Nutztierbiologie
Dummerstorf in Kooperation mit der Universität Rostock erweiterte sie ihre Methoden um Precision Livestock Farming (PLF). Die Bioinformatikerin Nina Melzer weihte sie in technische Möglichkeiten zwischen Tieren und Daten und die passende Programmierung ein.


Niemand kann 24 Stunden seine Kühe einzeln im Auge behalten oder Videos auswerten und gleichzeitig Unterschiede der Einzeltiere im Vergleich zum großen Bestand erkennen.
„Wenn Precision Livestock Farming gut gemacht ist, können die Landwirt:innen in der Analyse sehen, wenn etwas schiefläuft. Kameras im Stall zu installieren und ein Software-Abo für die Analysen abzuschließen bedeutet keine riesigen Investitionen.“ Sie geht davon aus, dass PLF eine ähnlich rasante Entwicklung erleben wird wie die Nutzung von Smartphones und Netflix-Abos. Über diesen Umweg könnte das Tierwohl auch gegenüber
Konsument:innen belegt und der Arbeitsplatz Milchwirtschaft bei Betriebsübergabe oder Personalsuche attraktiver werden.
Nach vier Jahren als Postdoc am interdisziplinären Animal Welfare Programme der Faculty of Land and Food Systems der University of British Columbia in Vancouver (Kanada), wo sie lernte, „auf Tierhaltung nicht nur durch die Veterinärinnenbrille zu sehen“, möchte sie am Institut für Tierschutzwissenschaften und Tierhaltung die Forschung am Kreuzungspunkt von positivem Sozialverhalten und automatisierten Messmethoden vorantreiben und so Verhaltensänderungen als Indikatoren nutzbar machen. Eine Ausweitung von Foris‘ Fokus auf Schweinehaltung würde sich angesichts ihrer Expertise ebenfalls anbieten. Schließlich sollen sich nicht nur Rinder sauwohl fühlen.
Was wissen die meisten Menschen nicht über Kühe?
Dass sie sich liebend gerne an einer Bürste kratzen.
Was ist Ihr Geheimrezept für die eintönige, anstrengende Videoauswertung?
Faustregel: Nie mehr als vier Stunden am Tag Videos analysieren. Und als Motivation: Wenn ich nicht genau hinsehe, treffen wir vielleicht schon zu Beginn falsche Entscheidungen für die Datenauswertung, die dann in den Betrieben genutzt wird.
Worauf freuen Sie sich in Wien?
Ich freue mich darauf, wieder in einer europäischen Stadt zu leben. Vancouver und Wien wechseln sich ab in der Top-Platzierung der lebenswertesten Städte.
Ich war vor 15 Jahren zuletzt regelmäßig in Wien und werde die Stadt neu entdecken.
Der letzte Ausbruch von MILZBRAND (Anthrax) bei Rindern wurde in Österreich 1988 gemeldet. Man könnte also davon ausgehen, dass die Milzbrandgefahr in Österreich gebannt ist. Leider könnten jedoch durch den Klimawandel Sporen des Milzbranderregers Bacillus anthracis, die bis jetzt im Boden schlummerten, wieder verbreitet werden. Da Bacillus anthracis ein Zoonoseerreger ist, kann es zu erneuten Ausbrüchen bei Tieren und Menschen kommen. Zudem gilt Anthrax als Biowaffe. Die Vetmeduni und das Bundesheer arbeiten daher gemeinsam an einer Verbesserung der Bioforensik des Erregers und bereiten sich so auf eine rasche, abgestimmte Gefahrenabwehr vor.
Milzbranderreger:
Teamwork in der Gefahrenabwehr
Der Boden trägt uns und nährt uns. Er speichert und bewahrt Nützliches wie Nährstoffe, Grundwasserreserven oder historische Spuren, aber auch Schädliches wie Schwermetalle, Pestizide oder Krankheitserreger. Zum Erbe heimischer Böden gehören neben chemischen Altlasten aus Deponien und Fabriken auch biologische Altlasten an Gerberei-Standorten und historischen Tierverscharrungsorten (Wasenplätzen).
So ist zum Beispiel bei der Verarbeitung von Tierhäuten häufig der Zoonoseerreger Bacillus anthracis in die Produktionsstätten eingeschleppt worden. Das Bakterium B. anthracis kann bei Menschen und Tieren Milzbrand verursachen. Das typische Erscheinungsbild von mit Milzbrand befallenen Rindern und Schafen ist recht eindeutig: Sie bluten aus allen Körperöffnungen. Verendete Tiere wurden in der Vergangenheit oftmals an Ort und Stelle eingescharrt. Da B. anthracis Sporen bildet, die im Boden viele Jahrzehnte überdauern können, stellen diese Orte potenzielle Quellen für neue Ausbrüche dar. So können scheinbar erloschene oder aktuell unbekannte Milzbrand-Herde

zum Beispiel durch Erdumwälzungen wie bei Gussregen oder Murenabgängen wieder aktiv werden und erneut zu Ausbrüchen führen.
Anthrax kann jedoch auch als potenzielle Biowaffe eingesetzt werden. Es ist daher eine enge Zusammenarbeit zwischen verschiedenen Akteur:innen erforderlich, um natürliche Ausbrüche von vorsätzlichen Kontaminationen zu unterscheiden. Im Rahmen des FFG-FORTE-Projekts EuroThrax, einem Kooperationsprojekt der Vetmeduni und dem Amt für Rüstung und Wehrtechnik (ARWT) des Bundesheers, wird deswegen eine bioforensische Datenbank zur Erfassung der phylogenetischen Verbreitung des Milzbranderregers entwickelt. Im Zentrum des Projekts stehen die Detektion und Genomik von Bacillus anthracis sowie nah verwandter Bakterienarten aus der Bacillus cereus-Gruppe.
In Österreich ist der letzte Milzbrand-Ausbruch 1988, also vor 45 Jahren, in Tirol ge-
Text: Monika Ehling-Schulz, Astrid Kuffner, Maximilian Mayerhofer • Fotos: Maximilian Mayerhofermeldet worden. Da in Folge der Klimaerwärmung Starkwetterereignisse wie Überschwemmungen, Dürreperioden etc. häufiger auftreten werden, ist es nur eine Frage der Zeit, bis mit Anthrax-Sporen belastete Böden aufgewirbelt, freigelegt oder verteilt werden könnten. In Nachbarländern ist es in den zurückliegenden Jahren bereits zu Ausbrüchen gekommen. „Der Keim hat, nicht weit entfernt von historischen Orten in Österreich, überlebt. Starkregen kann zu Bodenumwälzungen führen und bei langen Trockenperioden können Gebiete zugänglich werden, die lange von Wasser bedeckt waren“, erläutert Monika Ehling-Schulz, Leiterin des Instituts für Mikrobiologie der Vetmeduni. „Wir müssen die Verbindungen zwischen Mensch, Tier und Umwelt verste-
hen, um wirksame Maßnahmen zur Prävention und Kontrolle von Anthrax-Ausbrüchen zu entwickeln.“
Im Rahmen des EuroThrax-Projekts entwickeln Vetmeduni und Bundesheer gemeinsam eine Datenbank, die eine schnelle und abgestimmte Reaktion auf potenzielle Anthrax-Bedrohungen ermöglicht. Die Studienleiterin Monika Ehling-Schulz betont die Wichtigkeit dieser Kooperation: „Genomdaten werden mit den verfügbaren Meta-Daten verknüpft und somit quasi eine biologische ‚Lagekarte‘ erstellt, die es ermöglicht, neu auftretende Ausbrüche rasch
 Maximilian Mayerhofer vom Amt für Rüstung und Wehrtechnik (ARWT) des Bundesheers arbeitet gemeinsam mit der Vetmeduni am FFGFORTE-Projekt EuroThrax.
Maximilian Mayerhofer vom Amt für Rüstung und Wehrtechnik (ARWT) des Bundesheers arbeitet gemeinsam mit der Vetmeduni am FFGFORTE-Projekt EuroThrax.
Bodenproben werden mit Handbohrern in Schutzausrüstung entnommen. Je nach Bodenbeschaffenheit können Tiefen bis zu vier Metern erreicht werden. An historischen Standorten können Tierhaare oder Knochen an Bohrstellen nützliche Hinweise liefern. Das Bohrgut wird in Gefäßen für den Transport verpackt und anschließend im Labor analysiert.



einordnen zu können.“ Dies führt zu einer effizienteren Überwachung und Reaktion auf Anthrax-Ausbrüche und schafft letztendlich die Grundlagen für entsprechende Präventionsstrategien.
Grundlage dieser Datenbank bilden publizierte Daten von Ausbrüchen auf der ganzen Welt. Diese werden ergänzt durch Daten aus Archivarbeiten, Untersuchungen von historischen Anthrax-Orten und Ganzgenomsequenzierungen im Rahmen von EuroThrax. Eine sorgfältige Archivarbeit sowie Kooperation sind ein wichtiger Schlüssel für den Erfolg des Projekts. Archivdaten erlauben Rückschlüsse auf mögliche historische Milzbrand-Orte. „Diese in der Fachsprache Loci genannten Orte können sich zum Beispiel auf einer Alm oder auf einem alten Fabriksgelände einer Gerberei befinden“, erläutert Monika Ehling-Schulz.
Es ist daher wichtig, diese historischen Ausbruchsorte zu lokalisieren und dann eine mögliche Beprobung mit allen Stakeholder:innen abzustimmen. Die Bodenprobenahmen erfordern somit die Kooperation von Vetmeduni, Bundesheer, lokalen Besitzer:innen und der Veterinärbehörde. Diese gemeinsame Arbeit festigt das Zusammenspiel von Vetmeduni, Behörden und Besitzer:innen für den Ernstfall.
An einem alten Gerbereistandort in Österreich ist das EuroThrax-Team bereits fündig geworden. Es versucht nun mittels Genomik und Bioinformatik, die Herkunft des gefundenen Milzbrand-Erregers zu bestimmen.
„Wir haben die Methoden für die Isolierung der B. anthracis-Keime aus Böden adaptiert. Der Nachweis aus Böden in Texas oder der Savanne funktioniert mit anderen Nachweisgrenzen als in Lössgebieten oder den Alpen“, so Maximilian Mayerhofer, PhD-Student der Vetmeduni und Mitarbeiter des ARWT. Es wurden daher im Vorfeld der Untersuchungen an historischen Anthrax-Loci die Wiederfindungsraten und Nachweisgrenzen von B. anthracis für ausgewählte österreichische Böden mittels Laborversuche bestimmt sowie die Protokolle entsprechend angepasst und optimiert.
In der langen Tradition von Anthrax-Ausbrüchen und der Langlebigkeit von B. anthracis-Sporen liegt die Tücke. Monika Ehling-Schulz findet es daher wichtig, das Wetter und den Keim „im Auge zu behalten. Mit Awareness, optimierten Nachweismethoden und der von uns entwickelten Datenbank können wir vorbauen, falls durch Extremwetterereignisse Risikostandorte wieder aktiviert werden“.
Dieses Forschungsprojekt unterstreicht die Bedeutung des One-Health-Ansatzes. Nur durch eine ganzheitliche Betrachtung von Mensch, Tier und Umwelt kann ein umfassendes Verständnis der komplexen Zusammenhänge bei der Ausbreitung von Zoonosen, wie zum Beispiel Anthrax, erlangt werden. Die Erkenntnisse können nicht nur dazu beitragen, die Auswirkungen dieser Zoonose zu minimieren, sondern auch als Grundlage für präventive Maßnahmen dienen, um zukünftige Ausbrüche, beispielsweise durch ein Impfprogramm, zu verhindern.
BIRGIT DASTIG arbeitet im Bezirk Leibnitz als Gemischtpraktikerin, pendelt also zwischen Bestandsbetreuung und Kleintierbehandlung. Zur fünfköpfigen Familie der Tierärztin und zertifizierten Hundetrainerin gehört neben Assistenzhund Schoki meist ein weiterer Vierbeiner in Ausbildung. Neben der Ordination in Ragnitz hat sie eine karitative Organisation gegründet, die Assistenzhunde für Menschen mit besonderen Bedürfnissen ausbildet.
Interview: Astrid Kuffner • Foto: Privat
VETMED: Sie leiten gemeinsam mit einer Kollegin das Tiergesundheitszentrum (TGZ) in Ragnitz mit angeschlossenem Physiotherapiezentrum und Hundefrisör. Wie war der Einstieg in diesen Beruf?
Birgit Dastig: Ich bin nach dem Studium über ein Praktikum in Oberösterreich und eine Stelle als Assistentin in einer Rinderund Schweinepraxis in die Südsteiermark gekommen. Die Landwirte vor Ort haben mich bald gefragt, ob ich nicht in der Gegend bleiben möchte. 2004 habe ich mich selbständig gemacht, mit einer Ein-Raum-Praxis und meinem Mann als Sprechstundenhilfe. Uns wurde jedoch schnell klar, dass wir mehr Platz brauchen und so beschlossen wir zwei Jahre später eine neue Praxis zu bauen. Seit 2009 leiten Manuela Scherwitzel-Mandl und ich das TGZ gemeinsam.
Sie behandeln Groß- und Kleintiere. Konnten Sie sich nicht für ein Spezialgebiet entscheiden?
Steckbrief
Birgit DastigFachgebiet
Gemischtpraktikerin
Positionsbeschreibung
Praxisleitung und Mutter von drei Söhnen (11, 9 und 7 Jahre)
Derzeitiger Standort Ragnitz
Dastig: Am Land stellt sich diese Frage gar nicht, da werden Allrounder gebraucht. Bei mir ist es gewachsen. Momentan wechseln meine Kollegin und ich uns ab: Je eine ist fast 24 Stunden für Großtiere erreichbar und fährt auf Außenvisite. Die andere macht die Kleintiere. Aber wir beherrschen beide beides. Jede hat zudem ihr Steckenpferd, wie ich die Assistenzhunde, und wenn es nötig ist, packen wir gemeinsam an.
Sie bilden nebenbei auch Assistenzhunde für Menschen mit körperlichen Einschränkungen oder psychischen Erkrankungen aus. Wie kam es dazu?
Dastig: Ich bin selbst in meiner dritten Schwangerschaft zur Diabetikerin geworden und als Betroffene habe ich mich für Signalhunde interessiert. Meine Sprechstundenhilfe und ich haben dann gemeinsam die Ausbildung an der Akademie für angewandte Tierpsychologie und Tierverhaltenstraining (ATN) absolviert. Nebenbei

bilden wir immer wieder einen individuellen Assistenzhund für ein Kind mit besonderen Bedürfnissen aus und stellen über Spendenaktionen das Geld dafür auf.
Worauf müssen denn Tierärzt:innen bei Assistenzhunden achten?
Dastig: Es ist vor allem wichtig, sie nicht nur als Arbeitstier zu sehen. Man muss den Besitzer:innen und den Veterinär:innen klarmachen, dass der Spaß bei der Arbeit wichtig ist, es neben den „Dienstzeiten“ aber auch Spiel- und Ruhezeiten braucht.
Geht es viel um Prävention?
Dastig: In der Beratung ist es sinnvoll, die Besitzer:innen regelmäßig zur Vorsorge einzuladen. Wie auch bei Therapiehunden müssen regelmäßig Blut- und Kotproben abgegeben werden. Die Prüf- und Koordinierungsstelle für Assistenzhunde bzw. Therapiebegleithunde des Messerli Forschungsinstituts prüft regelmäßig, ob die Tiere noch einsatzfähig sind. Assistenzhunde unterliegen in allen Phasen – ab der Auswahl, während der Ausbildung, in der Betreuung und bis hin zur Nachschulung – strengen Qualitätskriterien, die von der Prüf- und Koordinierungsstelle kontrolliert werden.
Wie viele Hunde haben Sie bereits ausgebildet und wie lange dauert das?
Dastig: Wir sind jetzt beim vierten Hund und es dauert etwa zwei Jahre, bis er in die Familie gehen kann. Die Welpen kommen von heimischen Züchter:innen. Im ersten Jahr ist der Hund bei uns in den Familien mit Kindern und hält regelmäßig Kontakt zur künftigen Familie. Wir schulen den Hund und die Klient:innen im Umgang mit dem Hund. Es findet ein langsamer Übergang statt. Wenn der Hund in der Familie untergebracht ist, kommen wir dorthin und begleiten dann das Mensch-Hund-Team zur Prüfung.
Gibt es bestimmte Rassen für bestimmte Aufgaben?
Dastig: Wir suchen den richtigen Hund mit passender Größe, Körperbau und dem
geeigneten Charakter. Ein Hund muss seine Aufgabe leicht schaffen können. Etwa Dinge aufheben oder besonders gut riechen können. Es gibt Wesenstests und Gesundheitschecks, aber dennoch muss es nicht immer klappen.
Wie sieht ein gewöhnlicher Arbeitstag bei Ihnen aus oder gibt es genau den gar nicht?
Dastig: Wenn man Tierärztin wird, muss man mit Flexibilität umgehen können. Man kann schon planen, aber es passieren unvorhergesehene Dinge, weshalb das Arbeitsende nie planbar ist.
Wurden Sie als Frau in diesem Beruf immer akzeptiert oder haben Sie als Tierärztin abweichende Erfahrungen gemacht?
Dastig: Seit ich mich selbständig gemacht habe, nicht mehr. Was mir heute eher auffällt, ist die Vorstellung, als Tierarzt oder Tierärztin nur hochspezialisiert sowie ohne Wochenend- und Nachtdienste arbeiten zu wollen. Das ist für mich ein schiefes Berufsbild. Wir brauchen am Land Leute, die eine Katze im Notfall genauso versorgen können wie einem Schwein eine Spritze geben. Nur so kann ein 24-Stunden-Notdienst angeboten werden. Für alles andere gibt es Spezialkliniken.
Gab es für Sie Überraschungen zwischen Ausbildung und Praxis?
Dastig: Die Bürokratie ist mehr geworden. Als ich angefangen habe, gab es einen Bruchteil der Dokumentation und der gesetzlichen Vorschriften. Auch der buchhalterische Aufwand ist nicht ohne. Das Kaufmännische habe ich zum Glück zu Hause gelernt, das wurde an der Uni wenig behandelt.
Worin liegt für Sie der Reiz der Tätigkeit?
Dastig: Auch nach 20 Jahren habe ich jeden Tag neue Fälle und neue Menschen vor mir. In unserem Job wird es nie langweilig. Ich kann mich laufend weiterentwickeln.
Ich war an der Vetmeduni … … von 1996 bis 2002.
Mein Tipp an Absolvent:innen der Vetmeduni: Am besten vor dem Studium ein halbes Jahr im Beruf praktisch arbeiten, wie in Norwegen.
Mein Lieblingsort an der Vetmeduni war … … mein Balkon im Studentenheim gegenüber der Uni auf der Dachterrasse, wo ich an der frischen Luft gelernt und auch gegrillt habe.
Veranstaltung
VetmeduniTalk
Im Rahmen der Jahrestagung der Vereinigung österreichischer Kleintiermediziner:innen (VÖK) findet am 24. September 2023 der VetmeduniTalk zum Thema Assistenzhunde mit Expert:innen der Vetmeduni und Alumna Birgit Dastig statt. Die Teilnahme ist für Tagungsbesucher:innen kostenlos.

Probenentnahme am Tier 1
• Atemwege
• Haut und Weichgewebe
• Verletzung der Haut
• Harnwegsinfektion
• Gastrointestinale Infektion
• Milch
2
Proben
3
Auswahl der Tests / Beauftragung des Labors für Diagnostik
4 Anfertigung einer Resistenztestung
Kultivierung von Bakterien in unterschiedlichen Nährmedien [selektive und nichtselektive, feste (Agarplatten) und flüssige]
Inkubieren von Nährmedien
Dauer: zwischen 24h und 5 Tagen*, unter unterschiedlichen Temperaturen und unterschiedlichen
Atmosphären (aerob, mikroaerophil, anaerob)
Identifikation von Bakterien und Gewinnung der Reinkultur
Dauer: etwa 24h
ACHTUNG: Ohne Reinkultur gibt es kein Antibiogramm
Grafik: Matthias Moser, Redaktionelle Aufbereitung: Stephanie Scholz
Resistenztestung (Antibiogramm; meist: Agardiskdiffusionstest) sowie anschließendes Inkubieren
Dauer: bis zu 24h
Auswertung und Interpretation des Antibiogramms
Fachlicher Input: Igor Loncaric (Institut für Mikrobiologie), Clair Firth (Abteilung für Öffentliches Veterinärwesen und Epidemiologie), Frank Künzel (Universitätsklinik für Kleintiere)
5
Antibiogramm Auswahl des Antibiotikums
zeigt, welche Antibiotika gegen diese Bakterien wirken
6 7 Behandlung des Tiers
anhand der Wirksamkeit im Antibiogramm
Verabreichung des geeigneten Antibiotikums für die angegebene Dauer
Achtung! Im Akut- bzw. Notfall erfolgt eine sofortige Behandlung des Tiers. Gleichzeitig wird eine Probe genommen, um die richtige antibiotische Therapie zu bestätigen.
Eine Antibiotikaresistenz ist, wenn ...
... ein Antibiotikum nicht mehr gegen ein bestimmtes Bakterium wirkt.
Nicht der Mensch oder das Tier wird resistent, sondern ein einzelnes Bakterium.
Nichtkorrekter oder suboptimaler Einsatz von Antibiotika bei Mensch oder Tier kann die Entwicklung neuer Resistenzen oder die Verbreitung vorhandener Resistenzen fördern.
Im Fall der Fälle ... Die Kliniken der Vetmeduni sind im Notfall 24 Stunden am Tag, 7 Tage die Woche, 365 Tage im Jahr erreichbar.
24-Stunden-Telefon:
Kleintiere: +43 1 25077-5555
Pferde: +43 1 25077-5520
Nutztiere: +43 1 25077-5232
KAREN WAGENER ist auf einem Milchviehbetrieb groß geworden. Heute sucht sie als Forschende zwischen Klinik und Petrischale nach präventiven Ansätzen, um den Reproduktionstrakt von Kühen auch unter schwierigen Bedingungen wie Hitzestress gesund zu halten.

Text: Astrid Kuffner • Fotos: Thomas Suchanek/Vetmeduni
Karen Wagener, Assistenzprofessorin an der Klinischen Abteilung für Bestandsbetreuung bei Wiederkäuern, ist mit Kühen seit frühester Kindheit vertraut. Aufgewachsen ist sie auf einem landwirtschaftlichen Betrieb in Norddeutschland. Als Kind beim Melken und Ausmisten zu helfen, war nicht immer ein Spaß, eine akademische Laufbahn in ihrer Familie alles andere als selbstverständlich. Auch deshalb ist es ihr ein Anliegen, ihre Studierenden stets zu ermutigen: „Ich sage ihnen, dass sie an ihre Ziele glauben sollen, ihren Weg gehen trotz der Stolpersteine darauf.“
Die Herkunft erdet sie, auch wenn letztlich der Bruder den Hof übernahm und Karen Wagener, die immer mit Milchkühen arbeiten wollte, zum Studium der Veterinärmedizin nach Wien ging: „Die Kuh ist in meinen Augen ein Wunderwerk der Natur, weil sie als Wiederkäuer für uns Menschen nichtverdauliche Komponenten in wertvolle Nährstoffe, zum Beispiel Proteine, verwandelt.“
Die Laufbahn hin zur Forschungsgruppe der Abteilung Bestandsbetreuung, die an der VetFarm Kremesberg angesiedelt ist, bezeichnet sie als „fragegeleitet“, schrittweise „vom Groben ins Feine“. Ab dem Diplom ergaben sich aus jedem Forschungsaufenthalt und Ausbildungsschritt neben den
Antworten neue Fragen, die sie beantworten wollte. „Was fehlt mir dazu?“ führte sie als Leitgedanke nach dem Doktorat an der Funktionellen Mikrobiologie noch zu einem Masterstudiengang in Tissue Engineering and Regenerative Medicine an der FH Technikum Wien, um mehr molekularbiologische Methoden zu erlernen. Von dort ging es in eine tiefgreifende klinische Ausbildung in Reproduktionsmedizin, die sie mit dem Diplomate of the European College of Animal Reproduction (ECAR) abschloss.
Karen Wagener sieht sich als Bindeglied zwischen Klinik und Grundlagenforschung, wobei das eine mit dem anderen wechselwirkt. Ihr Spezialgebiet ist der Reproduktionstrakt der Milchkuh, den sie zusammen mit Kooperationspartnern von der Gebärmutter, dem Eileiter bis hin zu den Eierstöcken ergründet. Karen Wagener will die Synergien am Vetmeduni-Campus nutzen, sich mit Arbeitsgruppen vernetzen und sich so gegenseitig mit Ideen inspirieren. Sie erforscht vorwiegend das Immunsystem sowie die pathologische und physiologische bakterielle Besiedelung der Gebärmutter. Letztlich will sie herausfinden, wie ein unterstützendes Mikrobiom die Schleimhaut im Fortpflanzungsapparat schützen kann. Der Konnex zur Milchwirtschaft ist klar: ohne Reproduktion keine Laktation. Probleme bei der Fruchtbarkeit sind der Grund Nummer eins, warum eine Milchkuh aus den Beständen ausscheidet.
Was wissen die meisten Menschen nicht über Kühe?
Die Kuh macht überspitzt gesagt aus einem Abfallprodukt (Harnstoff) und aus Zeitung (Zellulose) – beides für uns unverwertbar – hochwertige Proteine. Das sage ich allen, die die Kuh abschaffen wollen.
Ihre Lieblingsmusik?
Italienische Schlager machen Laune.
Was vermissen Sie an Norddeutschland? Fischbrötchen! Und die Weite mit grünen Wiesen und Holsteinkühen. Dafür muss ich hier auf den Berg steigen, was ich auch gerne mache.
Prävention hat viele Pfeiler
Ihre Forschung nimmt ein komplexes Mosaik in den Fokus: die Milchkuh, ihren Reproduktionszyklus, klinische Symptome, die beteiligten Bakterien, das Immunsystem und die Umwelt des Tiers. „Angesichts des Klimawandels wird auch der Hitzestress im Stall zunehmen. Man weiß bereits, dass die Mikroben im Darm dadurch beeinflusst werden. Wir wollen das für den Reproduktionstrakt erforschen und gegebenenfalls Ansätze zur Prävention finden“, erklärt Wagener. „Der gesamte Reproduktionstrakt der Kuh, die Umwelteinflüsse und das Management müssen im Kontext betrachtet werden. In-vitro- und In-vivo-Forschung greifen ineinander, sodass wir bereits mehrere Einflussfaktoren auf die geminderte Fruchtbarkeit nachweisen konnten. Gleichzeitig sind viele Mosaiksteine noch unerforscht.“
Ihr Team macht auf der VetFarm und in kommerziellen Betrieben klinische Beobachtungen,

Angesichts des Klimawandels wird auch der Hitzestress im Stall zunehmen. Wir wollen das für den Reproduktionstrakt erforschen und Ansätze zur Prävention finden.
KAREN WAGENER
versucht mikrobiologische Belege in der Petrischale zu finden und kehrt mit möglichen Erklärungen und Behandlungsansätzen aus dem Labor in den Stall zurück. Für erfolgreiche Prävention braucht es solides Monitoring, das mögliche Erkrankungen im Lauf des Laktationszyklus anhand des Verhaltens der Kühe, von Daten (zum Beispiel Klimadaten) und Milchinhaltsstoffen früh aufzeigt. „Die präventiven Konzepte der Abteilung Bestandsbetreuung ergänzen sich also idealerweise mit meiner Grundlagenforschung“, so Wagener.
Sie hat bereits an der Vetsuisse in Zürich, der Swansea University in Großbritannien, in den Pampas von Argentinien und an der University of Florida geforscht. Aktuell radelt sie bei gutem Wetter durch die Weinberge zur Arbeit und sieht es als Privileg an, „direkt am Tier auszubilden und zu forschen“. Für sie ist es interessant, „das große Ganze zu sehen und im Detail daran zu arbeiten“.
Forschung nah am Tier: Muhittin Tekin, Karen Wagener und Elisabeth Hausmann pendeln auf der VetFarm Kremesberg zwischen Labor, Stall und Weide.
Unsere Gesundheit hängt wesentlich von einer ausgewogenen, hochwertigen Ernährung ab. Doch Nahrung ist noch viel mehr: zum Beispiel Genuss, Freude, soziales Erlebnis und politisches Statement. Was wir essen, hat nicht nur Auswirkungen auf unser Wohlbefinden, sondern auch auf Umwelt, Tiere und Klima. Im zweiten Quartal 2023 widmete sich die Vetmeduni deshalb in ihrer SDG-Schwerpunktkommunikation dem Aspekt von Gesunder Nahrung. Ausgehend vom One-Health-Gedanken forscht, lehrt und praktiziert die Veterinärmedizinische Universität Wien und präsentiert die neuesten Forschungsergebnisse im Zuge ihrer Nachhaltigkeitsoffensive einer breiten Öffentlichkeit mittels Veranstaltungen, Podiumsdiskussionen, Videos und Social-Media-Kampagnen.
Soll man rohes Fleisch waschen? Entstehen multiresistente Keime durch den Antibiotikaeinsatz in Ställen? Schmecken glückliche Tiere besser? Und wie wirkt sich die globale Teuerung auf unseren Lebensmittelkonsum aus? Diese und weitere Fragen diskutierten Expert:innen beim zweiten VetmedTalk „So schmeckt das Leben“. Der VetmedTalk deckte dank der Expertise der Diskussionsteilnehmer:innen die vielfältigen Aspekte des Themas Gesunde Nahrung ab. Im Zentrum stand die Frage, was die Veterinärmedizin im Sinne des One-Health-Gedankens dazu beitragen kann, dass gesunde und genussvolle Ernährung auf der Grundlage von Tierwohl und Klimaschutz möglich ist.

Am 23. Mai sprach Peter Paulsen (Abteilung für Hygiene und Technologie von Lebensmitteln) beim Pint of Science und präsentierte in lockerer Baratmosphäre seine Forschung zur mikrobiologischen Beschaffenheit des Döners. Neben wissenschaftlichen Fakten kam auch der Humor nicht zu kurz. Oder haben Sie schon einmal darüber nachgedacht, wie die Geschichte verlaufen wäre, wenn Wilhelm Tell seinem Sohn einen Döner statt eines Apfels auf den Kopf gesetzt hätte?

Heimische Lebensmittel stehen für Sicherheit, Qualität und Genuss. Um das sicherzustellen, leisten Tierärzt:innen einen ganz wesentlichen Beitrag.“
Katharina Koßdorff
Fachverband Nahrungsund Genussmittelindustrie, WKÖ
Die Nachfrage beeinflusst das Angebot, daher mein Appell an die Verbraucher:innen: Bleiben Sie informiert und kritisch, denn damit können wir alle Veränderungen hin zu mehr Tierwohl bewirken!“
Karin Schwaiger



Abteilung für Hygiene und Technologie von Lebensmitteln, Vetmeduni
Gesunde und qualitativ hochwertige Lebensmittel können nur von gesunden Tieren produziert werden. Tierärzt:innen und der neue Tiergesundheitsdienst stehen vor der Herausforderung, Krankheiten vorzubeugen, einen verantwortungsvollen Arzneimitteleinsatz sicherzustellen und damit einen wichtigen Beitrag zur Nachhaltigkeit zu leisten.“
Simone Steiner Verein Tiergesundheit Österreich
Es gibt kaum Entscheidungen im Leben, die auf täglicher Ebene so einen großen Einfluss haben wie unser Lebensmitteleinkauf. Es geht hier auch um soziale Fragen zu Gerechtigkeit und Klimaschutz. Konsument:innen sind hier die entscheidenden Treiber:innen, deshalb meine Bitte: Nehmen Sie das ernst!“
Martin Wagner
Department für Nutztiere und öffentliches Gesundheitswesen in der Veterinärmedizin, Vetmeduni
 Expert:innen im Zitat
Text: Veronika Steiner
Expert:innen im Zitat
Text: Veronika Steiner










Dotierung: 1.200 Euro
Einreichfrist: 31. Oktober 2023
Die Gesellschaft der Freunde der Veterinärmedizinischen Universität Wien vergibt alljährlich Begabtenstipendien an drei Studierende des Diplomstudiums Veterinärmedizin. Bewerben können sich Studierende ab dem vierten Studienjahr, die sich innerhalb der Regelstudienzeit befinden und eine hervorragende Studienleistung aufweisen.
Für die Bewerbung um das Stipendium sind folgende Unterlagen vorzulegen:
• formloses Bewerbungsschreiben mit allen Kontaktdaten
Wissenschaftsvermittlung
Armin
Nach dem ehemaligen Ordinarius für Physiologie an der Tierärztlichen Hochschule Armin Tschermak, Edler von Seysenegg (1870–1952) benannt, honoriert der Armin Tschermak von Seysenegg-Preis jährlich akademischen Nachwuchs der Veterinärmedizinischen Universität Wien für herausragende wissenschaftliche Arbeiten. Für das Jahr 2022 wurde Christof Bertram mit dem Preis ausgezeichnet.
Erforschung von pathologischen Prognosekriterien
Christof Bertram studierte Tiermedizin an der Freien Universität Berlin. Nach seiner Dissertation an der FU Berlin kam er 2021 an die Vetmeduni und forscht im Bereich der Tumorpathologie und automatisierten Bildanalyse. Mit seiner interdisziplinären Tumorforschung verfolgt er eine Verbesserung der Genauigkeit und Reproduzierbarkeit von pathologischen Prognosekriterien. In der Arbeit mit dem Titel „Computer-assisted mitotic count using a deep learning-based algorithm improves interobserver reproducibility and accuracy“ untersuchte er zusammen mit einem internationalen Forschungsteam die Vorteile eines Bildanalysealgorithmus basierend auf künstlicher Intelligenz zur Unterstützung von Patholog:innen bei der Mitosezählung, ein wichtiges mikroskopisches Kriterium zur Beurteilung der Bösartigkeit von Tumoren. Die Ergebnisse von 23 Studienteilnehmer:innen haben einerseits die niedrige Reproduzierbarkeit zwischen Patholog:innen für die herkömmliche Methode bestätigt und andererseits gezeigt, dass der entwickelte Bildanalysealgorithmus zu einer deutlichen Verbesserung der Messung führt.

„Computer-assisted mitotic count using a deep learning-based algorithm improves interobserver reproducibility and accuracy“ von Christof Bertram et al.
• eine vollständige Abschrift der Studiendaten aus VetmedOnline
Einreichung: Elektronisch an international@vetmeduni.ac.at
Weitere Informationen und aktuelle Updates zu Stipendien und Preisen unter: www.vetmeduni.ac.at/studium/ studienorganisation/stipendienpreise-foerderungenservices
Tschermak von Seysenegg-Preis 2022
Die Gesellschaft der Freunde der Veterinärmedizinischen Universität Wien wurde 1959 gegründet, um die Veterinärmedizinische Universität Wien zu unterstützen. Sie finanziert sich und ihre Leistungen hauptsächlich durch Mitgliedsbeiträge und unterstützt auf Antrag verschiedene soziale Aktivitäten. Derzeit werden folgende Preise und Stipendien vergeben: Josef Bayer-Medaille, Armin Tschermak von Seysenegg-Preis, Farm Animal Award, Companion Animal Award sowie Begabtenstipendien für Studierende. Drei Arbeitskreise betreuen zudem verschiedene Förderbereiche: Heimtierkreis, Absolvent:innenverband, Arbeitskreis Pferde und Nutztiere.
Die Alumni-Karte kann von Mitgliedern der Gesellschaft der Freunde der Veterinärmedizinischen Universität Wien kostenlos bestellt werden, sofern diese Absolvent:innen der Vetmeduni sind. Die Alumni-Karte bietet Mitgliedern eine Vielzahl an Vergünstigungen – unter anderem in Museen, Kultur- und Freizeiteinrichtungen, sowie vielen anderen Institutionen. Ihre persönliche Alumni-Karte bestellen Sie bitte beim Generalsekretariat office@vetheim.at unter Angabe von Titel, Vorname, Nachname und Geburtsdatum. Außerdem wird ein Porträtfoto mit mindestens 300 dpi benötigt.
Alle Informationen zur AlumniKarte online unter: www.freunde-der-vuw.at/tiki/ Alumni-Card



Kommentar der Hochschüler:innenschaft der Veterinärmedizinischen Universität Wien (HVU)
Nach der diesjährigen ÖH-Wahl im Mai dürfen wir den neuen Vorsitz der Hochschüler:innenschaft der Veterinärmedizinischen Universität Wien (HVU) präsentieren. Es freut uns, dass sich Thomas Holzleitner und Ludwig Großpointner in den nächsten zwei Jahren weiterhin für die Interessen der Studierenden einsetzen dürfen. Ebenso erfreulich ist, dass wir mit Magdalena Galler nun auch weibliche Unterstützung im Vorsitz haben!
Ein großer Dank geht an das scheidende Mitglied des Vorsitzes, Benjamin Arnold, der die HVU zuletzt mit seiner Expertise mitgeprägt hat. Wir wünschen ihm weiterhin alles Gute und bedanken uns für die gute Zusammenarbeit im letzten Jahr!
Wir werden uns auch in Zukunft mit viel Motivation und Tatendrang für die Studierenden einsetzen. Natürlich haben wir uns auch neue Ziele für die nächsten zwei Jahre gesteckt, die wir verfolgen werden. Wir freuen uns auf den gemeinsamen Austausch und auf viele Begegnungen am Campus! Außerdem steht allen die Möglichkeit offen, bei uns in den HVU-Räumlichkeiten im Gebäude DA vorbeizuschauen!
Für Absolvent:innen Die Alumni-Karte der Gesellschaft der Freunde der Veterinärmedizinischen Universität Wien bietet Alumni viele Vorteile und ist kostenlos.
Das Team der HVUVorsitzenden lädt alle Studierenden ein, sie in ihren Räumlichkeiten besuchen zu kommen.


MEIN FORSCHUNGSPROJEKT IN 2.000 ZEICHEN
Forscherin: Cynthia Sohm ∙ Abteilung: LFG Vetfarm, Öffentliches Veterinärwesen und Epidemiologie, Klinische Abteilung für Wiederkäuermedizin

Leptospirose ist eine weltweit auftretende Zoonose, die durch das Bakterium Leptospira spp. ausgelöst wird. Auf Grund des Klimawandels wird in Europa in Zukunft mit einem verstärkten Auftreten gerechnet. Leptospiren besiedeln die Nieren und werden über den Urin ausgeschieden; die Übertragung erfolgt direkt über Kontakt der Schleimhäute oder Hautverletzungen mit Urin oder indirekt über kontaminierte Umwelt. Für den Nachweis einer Infektion mittels Mikroagglutinationstest (MAT) kommen lebende Bakterienkulturen zur Anwendung. Das Test-Panel sollte lokal zirkulierende Stämme umfassen, um die Sensitivität/Empfindlichkeit des Tests zu verbessern. Die serologische Diagnostik stützt sich allerdings derzeit auf „fremde“ Stämme, da bis dato kein isolierter Stamm aus Österreich verfügbar ist.
Das Projekt LORN zielt darauf ab, lokale Leptospira-Stämme von Rindern aus Niederösterreich zu isolieren und damit die Empfindlichkeit des MAT zu verbessern. Gemeinsam mit Kolleg:innen haben wir 410 Rinder aus Niederösterreich beprobt. Unser Fokus lag auf Kühen mit Symptomen, die auf Leptospirose hinwiesen, routinemäßig geschlachteten Rindern von Betrieben mit erhöhtem Leptospirose-Risiko sowie am Schlachthof ausgewählten Rindern.
Wir entnahmen Urinproben von symptomatischen Kühen sowie Nieren- und teilweise auch Urinproben von geschlachteten Rindern. Das Screening erfolgte mittels PCR-
Testung bei der Österreichischen Agentur für Gesundheit und Ernährungssicherheit (AGES) in Mödling. Leptospiren-DNA konnte bei sechs Urin- und drei Nierenproben nachgewiesen werden. Bei den Nierenproben gelang uns auch eine Anzucht der Bakterien. Die Isolate, welche alle demselben Stamm angehören, werden bei der AGES aufbewahrt und können künftig für die Routinediagnostik verwendet werden – der erste Schritt, um die Diagnostik zu optimieren.
Des Weiteren trägt das Projekt zu einem besseren Verständnis der Epidemiologie der Leptospirose in Österreich bei und soll die am stärksten exponierten Arbeitnehmer:innen (Landwirt:innen, Tierärzt:innen, Schlachthofarbeiter:innen etc.) über das zoonotische Risiko dieses spezifischen Erregers aufklären.
Gewinnfrage beantworten und eine VetmeduniGeldbörse aus recycelten Fahnen und Bannern der Wiener Designerin Anne Hermine gewinnen!

Gewinnfrage Was wird bei der Anfertigung einer Antibiotika-Resistenztestung eingesetzt?
a) ein Antibiogramm
b) ein PCR-Test
c) ein Antigen-Test
Mitmachen
Antworten können bis 27. Oktober 2023 an communication@ vetmeduni.ac.at geschickt werden. Alle korrekten und zeitgerecht abgegebenen Antworten nehmen an der Verlosung teil.
Auflösung der letzten Ausgabe: Katzen können bei Stürzen aus großer Höhe eine Maximalgeschwindigkeit von bis zu 100 km/h erreichen.
Cynthia Sohm ist Dissertantin an der Abteilung für Öffentliches Veterinärwesen und Epidemiologie und widmet sich der Erforschung von Leptospirose bei Rindern.
Fördergeber des Forschungsprojekts zur Leptospirose bei Rindern ist das Amt der Niederösterreichischen Landesregierung.
Faszination für Massenspektrometrie: Im Masterstudium hat Elisabeth Varga „ihre“ Technik gefunden, mit der sie neue Toxine identifiziert und die Giftmenge quantifiziert.
ELISABETH VARGA , neue Assistenzprofessorin für Analytische Chemie, Lebensmittel- und Umweltanalytik, wurde durch die Faszination für die Massenspektrometrie zur Forscherin. An der Vetmeduni wird sie weiterhin zu Pilz- und Algentoxinen arbeiten und sich mit der Prüfung der Qualität von Fleisch beschäftigen.
Text: Astrid Kuffner • Fotos: Michael Bernkopf/Vetmeduni
Wenn wir nur zwei Schlagworte hätten, um die neue Assistenzprofessorin Elisabeth Varga zu beschreiben, wären das „natürliche Toxine“ und „Massenspektrometrie“. Wer an dieser Schnittstelle eine sattelfeste chemische Analytikerin mit wachem Interesse für Neues sucht, ist bei ihr richtig. Im August 2022 wurde sie etwa vom Leibniz-Institut für Gewässerökologie und Binnenfischerei (IGB) in Berlin kontaktiert, um gemeinsam das massive Fischsterben an der Oder in Polen und Deutschland aufzuklären. Doch dazu später.
Ihre wissenschaftliche Karriere begann sie mit dem Bachelor in „Lebensmittelwissenschaft und Biotechnologie“ und dem Master „Safety in the Food Chain“ an der Universität für Bodenkultur Wien (BOKU). Nach der Dissertation am Department für Agrarbiotechnologie (IFA Tulln) forschte sie mit einem Erwin-Schrödinger-Auslandsstipendium des Wissenschaftsfonds in Dänemark und Wien zu Algengiften. Zuletzt war die gebürtige

Wienerin, aufgewachsen in Floridsdorf, am Institut für Lebensmittelchemie und Toxikologie der Fakultät für Chemie der Universität Wien. „Für mich war eine breite Ausbildung wichtig. Ich lege Wert darauf, in interdisziplinären Projekten mit angrenzenden Disziplinen zu arbeiten. Entsprechend freue ich mich schon auf die Kooperationen innerhalb der Vetmeduni, wo ich meine Expertise einbringen, aber auch neue Anwendungsfelder erschließen kann.“
Elisabeth Varga bringt reichlich Erfahrung mit Mykotoxinen (Pilzgiften) mit, weil das IFA Tulln hier eine Hochburg darstellt. Mit dem Forschungsaufenthalt in Dänemark erarbeitete sie sich eine umfangreiche Expertise im Bereich Phykotoxine (Algengifte). Diese war beim massiven Fischsterben an der Oder gefragt, als der Verdacht auf die Mikroalge Prymnesium parvum fiel: „Ich wurde angerufen, ob ich diese Alge und ihre Toxine kenne und sie analysieren kann. Das habe ich bejaht und den Nachweis erbracht.“
Die Antwort ist typisch für die Art, wie sie ihre Arbeit anlegt: die aktuelle Forschung kennen und vorantreiben, sich auf Konferenzen und mit Publikationen auf dem neuesten Stand halten und das Wissen für den Einzelfall passend einsetzen. Eine Massenblüte der grünen Mikroalge setzte Prymnesine frei, die Kiemenzellen schädigen und durch eine überschießende Immunreaktion letztlich zum Ersticken der Fische führen.
Immer kommt bei ihren Analysen die Massenspektrometrie zum Einsatz. Der Faszination für diese Technik ist Elisabeth Varga im Masterstudium „verfallen“. Sie begeistert sich vor allem für die Kopplung mit Flüssigkeitschromatographie, vom Screening über die Identifikation neuer Toxine samt verstoffwechselter Produkte (Metabolite) bis hin zur Quantifizierung von Kontaminanten. Immer wieder werden auch Kot-, Urin- und Plasmaproben ans Labor geliefert, „die bei der Vorbereitung recht geruchsintensiv sein können. Solche Schwierigkeiten sind aber zu überwinden“.

Bei der Grundlagenforschung zu den Algen hätte ich mir nie gedacht, dass ich letztlich an der Lösung eines großen Problems wie dem Fischsterben direkt mitarbeiten würde.
ELISABETH VARGA
An der Fakultät für Chemie wurde Elisabeth Varga von den Studierenden wiederholt unter die besten zehn Lehrenden gewählt: „Das Wichtigste ist für mich der Respekt für die Studierenden. Ich nehme Rücksicht auf ihre Bedürfnisse und Interessen, verknüpfe meine Themen mit parallel gelehrten Inhalten, damit es keine Dopplungen, sehr wohl aber Anknüpfungspunkte gibt. Gerne nehme ich auch Anschauungsobjekte mit in die Vorlesungen.“ Für sie als Analytikerin ist es wichtig, dass Studierende nicht nur vorgegebene Rechenwege befolgen, sondern selbst nach passenden Möglichkeiten der Analyse von Datensets suchen und die Ergebnisse auf Plausibilität prüfen.
Die Arbeit an einer Universität ist genau ihr „Ding“, „weil ich gerne mit anderen und für andere Leute arbeite, aber Flexibilität brauche und mitbestimmen will, was ich tue. In der Industrie werden manchmal Projekte, die einfach noch etwas Zeit gebraucht hätten, abgebrochen. Bei der Grundlagenforschung zu den Algen hätte ich mir nie gedacht, dass ich letztlich an der Lösung eines großen Problems wie dem Fischsterben direkt mitarbeiten würde.“ Entscheidend sind für sie die Vernetzung und der Austausch mit anderen Forschenden. Bestehende Kontakte auffrischen und neue knüpfen gelingt ihr auf Konferenzen. Nächste Gelegenheit für viel Interaktion und neue Ideen ist die im Herbst in Japan stattfindende Konferenz „Harmful Algae“, genau zum Spezialgebiet der neuen Assistenzprofessorin.
Was ist Ihr Raketentreibstoff?
Ich bin ein Workaholic. Für mich ist das kein Job, sondern eine Berufung.
Lieber Stadt oder Land als Lebensraum?
Beides! Kultur- und Sportangebot in Wien, aber schon als Kind habe ich Wochenenden und Ferien stets im mittleren Burgenland verbracht.
Haben Sie Spitznamen für die technischen Geräte?
An der Vetmeduni tragen alle Geräte Namen. Ich selbst mag diese Personalisierung nicht und benenne die Geräte lieber mit ihren technischen Bezeichnungen.

Text: Clara Ginther und Franz Michlmayr
Zentraler Ort am Campus
Krankheiten der heimischen Süßwasserfische Diese Neuerscheinung, verfasst von einem erfahrenen Autor:innenteam, beschreibt Ursache, Verlauf und Symptome der Krankheiten bei heimischen Fischen in Aquakultur und in Freigewässern. Erregerbedingte Krankheiten (Virosen, Bakteriosen, Mykosen, Parasitosen), umwelt-, haltungs- und ernährungsbedingte Krankheiten, Tumore und tumorähnliche Krankheitsbilder, Missbildungen, Verletzungen und weitere Krankheiten werden ausführlich beschrieben und durch über 400 Farbfotos und viele mikroskopische Aufnahmen verdeutlicht.
Das Buch richtet sich an Tierärzt:innen, Biolog:innen, Fischzüchter:innen, Teichwirt:innen sowie an alle, die an Fischen interessiert sind.

Stallbau für die Biotierhaltung RINDER

Nachdem die Bedingungen in der Rinderhaltung vom natürlichen Lebensraum abweichen, ist die weitestmögliche Berücksichtigung des Sozial-, Nahrungsaufnahme-, Ruhe- und Fortpflanzungsverhaltens, aber auch der besonderen Bedürfnisse von Mutterkühen, Kälbern und zu behandelnden Tieren notwendig.
Die Funktionsbereiche im Laufstall, wie der Liegebereich, die Lauf- und Fressgänge, die Tränke, der Melkstand, die Weide, befestigte Auslaufflächen oder Treppen und Rampen, werden umfassend beschrieben. Der Ammoniakreduktion sind in dieser überarbeiteten und erweiterten Auflage mehrere Beiträge gewidmet.
Auf Planungsdaten folgen Planungsbeispiele zu verschiedenen Stallformen mit zahlreichen Illustrationen. Die Schritte zur Einreichung und zum Bauablauf im Genehmigungsverfahren und Kontaktdaten zum Bio-Verband, zu Kontroll- und weiteren Fachinformationsstellen sind angeführt.
Als öffentliche Bibliothek steht die Universitätsbibliothek auch allen an der Tiermedizin Interessierten zur Nutzung und Entlehnung offen (siehe QR-Code für nähere Informationen). Es findet sich nicht nur wissenschaftliche Literatur vor Ort, sondern auch Bücher zur Tierhaltung oder Bienenzucht sind Teil des Bestands.
Gemütliche Lektüre
Lounge-Bereiche mit aktuellen Tageszeitungen im Erdgeschoß sowie im ersten Stock laden gerade in den heißen Monaten in klimatisierter Umgebung dazu ein, sich zu vertiefen. Auch die begrünte Dachterrasse wird in den wärmeren Monaten gerne genutzt. Der Zugang erfolgt über den Lesesaal, weshalb Speisen leider nicht mitgenommen werden können, verschlossene Getränke jedoch schon.
Weitere Informationen zur Ausleihe:www.vetmeduni.ac.at/ universitaetsbibliothek/ services/ausleihe
Weismann, Thomas; Licek, Elisabeth; Hochwartner, Oliver: Krankheiten der heimischen Süßwasserfische, Ursachen und Symptome in Text und Bild
1. Auflage, 2023
Österreichisches Kuratorium für Landtechnik und Landentwicklung: Stallbau für die Biotierhaltung RINDER
4. Auflage, 2023



















